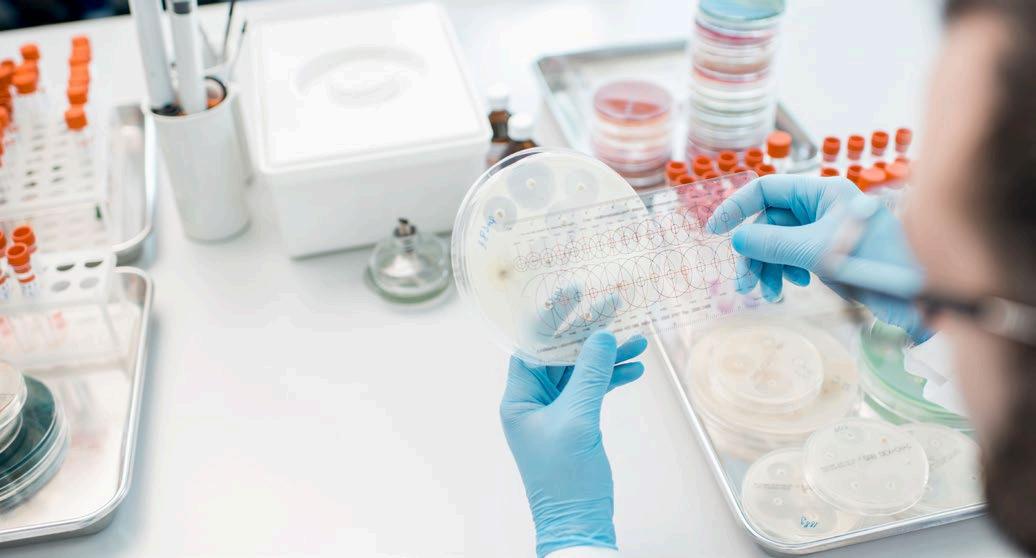

MICOTOXINAS ENEMIGAS INFILTRADAS DE LA SALUD Y LA PRODUCTIVIDAD PORCINA p. 30
Nº8 | Julio 2023

El cambio climático amenaza nuestra capacidad de garantizar la seguridad alimentaria mundial, erradicar la pobreza y lograr el desarrollo sostenible. Tiene efectos directos e indirectos en los sistemas agroalimentarios debido a regímenes de precipitaciones y temperaturas cambiantes e impredecibles, una mayor incidencia de fenómenos meteorológicos extremos y catástrofes como sequías e inundaciones y brotes de plagas y enfermedades.

FAO, 2023
Inmersos en plena ola de calor, el impacto del Cambio Climático en nuestras vidas es cada vez más evidente. Las condiciones climáticas extremas de las que ya nos avisaban los científicos hace décadas son una realidad innegable con previsiones de episodios de temperaturas extremas, sequías y tempestades cada vez más frecuentes e intensas.
Han corrido ríos de tinta sobre la contribución del sector ganadero, y el porcino en particular, al Cambio Climático. Sin embargo, un aspecto que requiere una atención y preparación pormenorizada es el impacto que tendrá el Cambio Climático en la producción porcina.
Lo primero que se nos viene a la mente es el aumento de las temperaturas, con olas de calor cada vez más prolongadas que pondrán a prueba nuestra capacidad para mitigar el estrés térmico en los cerdos, un fenómeno que tiene serias consecuencias para su salud y productividad, pudiendo observarse un aumento de la mortalidad, mayor propensión a desarrollar infecciones por un debilitamiento del sistema inmunitario y pérdidas de rendimiento reproductivo.
Por ello, la adaptación de las instalaciones y la optimización de los sistemas de climatización para lograr unas condiciones ambientales adecuadas con un consumo energético mínimo son objetivos que deben estar contemplados dentro de la estrategia de toda granja porcina para hacer frente al Cambio Climático.
Pero más allá de las variaciones térmicas, las amenazas del Cambio Climático vienen en la forma de escasez de recursos naturales y retos sanitarios.
CAPEANDO EL CAMBIO CLIMÁTICO EN LA PRODUCCIÓN PORCINA
Las condiciones climáticas extremas condicionan los rendimientos y la calidad de los cultivos de materias primas para alimentación animal, lo que unido al incremento de los costes y al agotamiento de los recursos hídricos, requerirá de la aplicación de medidas destinadas a maximizar el aprovechamiento y minimizar el desperdicio de estos recursos tan valiosos.
En este sentido, las estrategias basadas en la economía circular, el aprovechamiento de subproductos agroindustriales y la selección de animales con mayor capacidad de aprovechamiento de los recursos son estrategias que merecen ser exploradas.
En el ámbito sanitario, la tropicalización del clima conlleva un mayor riesgo de emergencia de enfermedades transmitidas por artrópodos vectores en áreas nuevas debido a cambios que favorecen su proliferación y, con ello, la propagación de patógenos.
Del mismo modo, los cambios en los patrones de infección de las cosechas con nuevas especies fúngicas micotoxigénicas nos obligará a replantear los protocolos de monitorización de micotoxinas en las materias primas y piensos, siendo necesario refinar los análisis, poniendo a punto técnicas analíticas y ampliando el espectro de toxinas a detectar.
Estos son solo algunos ejemplos de cómo el Cambio Climático impactará al sector porcino, siendo fundamental comprender en profundidad los puntos vulnerables de forma que se puedan implementar políticas y adoptar medidas que tengan en cuenta el contexto socioeconómico de las granjas y que permitan una sostenibilidad efectiva a largo plazo.
EDITOR
GRUPO DE COMUNICACIÓN AGRINEWS S.L.
DISEÑO GRÁFICO & WEB
Marie Pelletier
Enrique Núñez Ayllón
PUBLICIDAD
Laura Muñoz +34 629 42 25 52 laura@mediatarsis.com
Luis Carrasco +34 605 09 05 13 lc@agrinews.es
REDACCIÓN
Daniela Morales Osmayra Cabrera F.X. Mora
ADMINISTRACIÓN
Mercè Soler
Barcelona
España
Tel: +34 93 115 44 15 info@agrinews.es
www.porcinews.com
www.porcinews.com/revista-porcisapiens/
Precio de suscripción anual:
España 45 €
Extranjero 120 €
ISSN (Revista impresa) 2696-8142
ISSN (Revista digital) 2696-8151
DIRIGIDA A VETERINARIOS DE PORCINO
Depósito Legal PorciSapiens B 7620-2021
Revista Cuatrimestral
La
EDITORIAL
dirección de la revista no se hace responsable de las opiniones de los autores. Todos los derechos reservados. Imágenes: Noun Project/Freepik/Dreamstime/BioRender
1
4/15
MONITORIZACIÓN DE LA SALUD INTESTINAL EN PRODUCCIÓN PORCINA: BIOMARCADORES Y APLICACIONES
Óscar Mencía Ares y Marta Ferrer Ormad Exopol S.L.
16/22
VACUNACIÓN SIMULTÁNEA CON MÚLTIPLES
ANTÍGENOS: ¿SON COMPATIBLES EFICACIA Y FACILIDAD DE MANEJO?
M. Jiménez, M. Marcos y R. Menjón Servicio Técnico Porcino
MSD Animal Health
24/29
CLAVES DEL MANEJO Y ALIMENTACIÓN DEL PORCO CELTA
Manuel Martínez Ruiz Veterinario de ASOPORCEL
30/41
MICOTOXINAS. ENEMIGAS INFILTRADAS DE LA SALUD Y LA PRODUCTIVIDAD PORCINA

Panagiotis Tassis
Profesor Titular de Medicina y Reproducción Porcina Clínica de Animales de Producción, Facultad Medicina Veterinaria Universidad Aristóteles de Tesalónica, Grecia
42/55
PREVENCIÓN DE LA PESTE PORCINA AFRICANA - EVALUACIÓN DE LA BIOSEGURIDAD EXTERNA FRENTE A FAUNA SILVESTRE EN EXPLOTACIONES
PORCINAS INTENSIVAS
Mario Sebastián-Pardo1, Eduardo Laguna1, Daniel Hernández2, José Casanovas3 , Antonio Carpio1, Saúl Jiménez-Ruiz1,4, Pelayo Acevedo1, Ludovica Preite1, Jordi Baliellas5 , Llorenç Ricou 6 , Vidal Montoro1, Fernando Escribano7, María José Gens8 , Andrés Cuenca9, Carmen Teodora Morales Cuenca9, Carlos Martínez-Carrasco10, Gregorio Mentaberre11 y Joaquín Vicente1
1IREC (UCLM-CSIC-JCCM); 2INTERPORC, 3Cincaporc; 4GISAZ, Unidad de Investigación Competitiva ENZOEM; 5Grup de Sanejament Porcí; 6Cos d’Agents Rurals de Lleida, Generalitat de Catalunya; 7CRFS El Valle, ORTHEM; 8Consejería de Medio Ambiente, Mar Menor, Universidades e Investigación, Comunidad Autónoma Región de Murcia; 9Consejería de Agua, Agricultura, Ganadería y Pesca, Comunidad Autónoma Región de Murcia; 10Departamento de Sanidad Animal, Universidad de Murcia; 11Departamento de Ciencia
Animal, Universitat de Lleida, Wildlife Ecology & Health
56/60
PROTOCOLO DE BIOSEGURIDAD EXTERNA FRENTE A FAUNA SILVESTRE - APLICACIÓN Y VALIDACIÓN SOBRE EL TERRENO
Mario Sebastián-Pardo1, Eduardo Laguna1, Daniel Hernández2, José Casanovas3 , Antonio Carpio1, Saúl Jiménez-Ruiz1,4, Pelayo Acevedo1, Ludovica Preite1, Jordi Baliellas5 , Llorenç Ricou 6 , Vidal Montoro1, Fernando Escribano7, María José Gens8 , Andrés Cuenca9, Carmen Teodora Morales Cuenca9, Carlos Martínez-Carrasco10, Gregorio Mentaberre11 y Joaquín Vicente1
1IREC (UCLM-CSIC-JCCM); 2INTERPORC, 3Cincaporc; 4GISAZ, Unidad de Investigación Competitiva ENZOEM; 5Grup de Sanejament Porcí; 6Cos d’Agents Rurals de Lleida, Generalitat de Catalunya; 7CRFS El Valle, ORTHEM; 8Consejería de Medio Ambiente, Mar Menor, Universidades e Investigación, Comunidad Autónoma Región de Murcia; 9Consejería de Agua, Agricultura, Ganadería y Pesca, Comunidad Autónoma Región de Murcia; 10Departamento de Sanidad Animal, Universidad de Murcia; 11Departamento de Ciencia
Animal, Universitat de Lleida, Wildlife Ecology & Health
SUMARIO NO 8
62/75
ANTIBIÓTICOS Y CARNE: UN ENFOQUE NOVEDOSO EN LOS MÉTODOS DE VIGILANCIA


Dr. Ma Jesús Serrano Andrés Unizar-IA2
76/80
IMPACTO DEL CONTROL DE LA COCCIDIOSIS Y LA ANEMIA FERROPÉNICA EN LA CALIDAD DEL LECHÓN AL DESTETE
E. E. Udvarhelyi1, L. Villagrasa2, T. Abizanda2, O. Mitjana1, M.V. Falceto1, D. Espigares3 , L. Garza-Moreno1,3

1Departamento de Patología Animal, Universidad de Zaragoza
2Grupo Mazana
3CEVA Salud Animal
Agradecemos a nuestros anunciantes por hacer posible la publicación de esta revista: Boehringer Ingelheim, Ceva, MSD Animal Health, S.P. Veterinaria y Tashia.

WWW.PORCINEWS.COM/ REVISTA-PORCISAPIENS/
MONITORIZACIÓN DE LA SALUD INTESTINAL EN PRODUCCIÓN PORCINA: BIOMARCADORES Y APLICACIONES


a producción porcina actual está sometida a unos ritmos de producción muy exigentes, con unas condiciones de alojamiento, alimentación y manejo muy controladas y una gran estandarización de su genética. Todos estos factores influyen de forma decisiva en la salud intestinal de los animales, por lo que cada vez es más necesario el desarrollo de herramientas que nos permitan evaluar las intervenciones que realizamos en las explotaciones.


B
LL
SALUD INTESTINAL Monitorización de la salud intestinal en producción porcina: Biomarcadores y aplicaciones 4 Nº 8 | Julio 2023
Óscar Mencía Ares y Marta Ferrer Ormad Exopol S.L.
Descarga el PDF
¿QUÉ ENTENDEMOS POR
SALUD INTESTINAL Y QUÉ
RELEVANCIA TIENE EN LA PRODUCCIÓN PORCINA?
Un adecuado equilibrio entre el aparato digestivo y la microbiota intestinal residente es vital para garantizar el correcto funcionamiento del organismo. Esto se conoce como salud intestinal.

El intestino desempeña múltiples funciones entre las que se encuentran:
La digestión y la absorción de nutrientes.
La constitución de una primera barrera defensiva frente a la entrada de patógenos y sustancias nocivas para el organismo, como microorganismos, toxinas o metabolitos.
Además, cuenta con una gran cantidad de células inmunitarias presentes a lo largo de toda su pared, responsables del desarrollo y modulación de una función inmunitaria local que se traslada a nivel sistémico.
UNA SALUD INTESTINAL ÓPTIMA ES VITAL PARA GARANTIZAR UNA BUENA SALUD GENERAL DEL ANIMAL
El desarrollo de nuevas técnicas laboratoriales nos permite monitorizar determinados parámetros involucrados en la salud intestinal, obteniendo así resultados objetivos de dichas intervenciones que nos darán la información necesaria para desarrollar medidas preventivas encaminadas a conseguir una mejora de la salud digestiva porcina y, en definitiva, unos rendimientos productivos óptimos.
B
5 DIAGNÓSTICO
¿EN QUÉ TIPO DE MUESTRAS PODEMOS REALIZAR LA MONITORIZACIÓN DE LA SALUD INTESTINAL?
Para la monitorización de la salud intestinal se pueden emplear:
ABORDAJES NO INVASIVOS
Suponen una menor manipulación y, por tanto, menor estrés para los animales.
Un ejemplo de muestra recogida mediante este abordaje son las heces.
ABORDAJES INVASIVOS
Requieren de personal especializado y una mayor manipulación del animal, pero nos pueden dar una información más exacta de los cambios que se están produciendo, especialmente si se toman muestras de segmentos específicos del tracto gastrointestinal.


Ejemplos de muestras recogidas mediante este abordaje incluyen la sangre o los tejidos.
En producción porcina, el abordaje principal consiste en la monitorización de biomarcadores en muestras de heces, dada la relativa facilidad para su recogida.
Esta información puede complementarse con la evaluación de parámetros presentes en sangre, como marcadores inflamatorios o de estrés oxidativo, con el objetivo de dar una imagen completa del efecto que determinadas intervenciones tienen sobre el organismo del animal.
En la Tabla 1 se describen los principales abordajes para la toma de muestras, incluyendo los tipos de muestras que se pueden monitorizar para evaluar la salud intestinal en los cerdos.
SALUD INTESTINAL Monitorización de la salud intestinal en producción porcina: Biomarcadores y aplicaciones 6 Nº 8 | Julio 2023
ABORDAJE TIPO DE MUESTRA VENTAJAS LIMITACIONES
Técnica rápida y sencilla
Toma de muestra in vivo
No invasivo Heces
Implica un menor estrés para el animal

No requiere personal especializado
Posible imprecisión de los resultados (muestra muy heterogénea)
Valoración indirecta que no proporciona información exacta sobre el tramo del sistema digestivo donde se producen los cambios
Sangre
Técnica rápida y precisa
Muestra homogénea del funcionamiento general del organismo
Reducido coste
Invasivo
Contenido intestinal
Mucosa intestinal

TABLA 1
Muestra más idónea
Posibilidad de estudiar diferentes tramos del sistema digestivo de forma específica
Necesidad de personal especializado
Estrés en la manipulación, lo que puede alterar algunos parámetros
Elevado coste
Necesidad de personal especializado
Sacrificio del animal
Tipos de abordajes para la monitorización de la salud intestinal en cerdos.
En este artículo nos centraremos en los parámetros relacionados de forma directa con la salud intestinal.

7
DIAGNÓSTICO
¿QUÉ BIOMARCADORES SE EMPLEAN PARA EL ESTUDIO DE LA SALUD INTESTINAL?
Existe una amplia variedad de potenciales marcadores que se pueden emplear para la monitorización de la salud intestinal en la producción porcina. Estos biomarcadores pueden agruparse en base a las funciones en las que están involucrados, si bien todos ellos están interconectados (Figura 1).
Por ello, recomendamos realizar un abordaje integral de los diferentes biomarcadores, de manera que podamos obtener una imagen lo más completa y objetiva posible que permita:
Comprender el porqué de los cambios en los rendimientos productivos. Establecer una relación con las intervenciones realizadas.
Capa mucosa interna Torrente sanguíneo
Lámina propia
Toxina/Metabolito Defensinas
Célula de Paneth
1 2 Enterocito IFN-γ Calprotectina TGF-β
Bacterias Activación de linfocitos T y B
Mucina
Célula dendrítica IgA IgG
Maduración de linfocitos B Célula plasmática
FIGURA 1
SALUD INTESTINAL Monitorización de la salud intestinal en producción porcina: Biomarcadores y aplicaciones 8 Nº 8 | Julio 2023

Esquema de la interacción de la microbiota intestinal y la integridad de la pared intestinal con la respuesta inflamatoria local y sistémica (Adaptado de Peng J. y col. (2021); creado con BioRender.com).


A continuación, se detallan algunos de los biomarcadores más relevantes en la producción porcina. Capa mucosa externa Ensamblaje en la capa mucosa Célula caliciforme Neutrófilos Macrófago
ESTUDIO DE LA INTEGRIDAD Y LA INFLAMACIÓN INTESTINAL
La función de barrera y la función inmunitaria del intestino son posibles gracias a la unión de las células del epitelio intestinal (enterocitos) y a las células inmunitarias integradas en el epitelio y en la lámina propia de la mucosa intestinal.
En caso de que ocurran disrupciones de esta integridad, se produce un incremento de la permeabilidad transcelular, provocando el paso de compuestos perjudiciales para el organismo, como toxinas, microorganismos o sus propios metabolitos.

Como consecuencia, se desencadena una respuesta inflamatoria local a nivel de mucosa gracias a la liberación de precursores inflamatorios, como citoquinas, por parte de las células inmunitarias allí presentes (linfocitos o macrófagos).
Esta respuesta inmunitaria se puede trasladar a nivel sistémico, generando una respuesta inflamatoria generalizada que afectará a la salud general del animal y, consecuentemente, a los rendimientos productivos.

En la actualidad, la evaluación de la integridad intestinal y la respuesta inflamatoria local en producción porcina se basa en el estudio de la expresión génica de las células presentes en la mucosa intestinal (enterocitos y células inmunitarias), lo que permite valorar si determinadas intervenciones provocan cambios en su expresión entre un grupo experimental (por ejemplo: cambio de estrategia nutricional, inclusión de aditivos o cambios de manejo) y un grupo control, con la variable a estudiar como única diferencia entre ambos grupos.
PARA VALORAR LA EXPRESIÓN GÉNICA, LA DIANA ES EL ARN MENSAJERO (ARNm)
PRODUCIDO POR ESTAS CÉLULAS, UNA
MOLÉCULA INTERMEDIARIA ENTRE EL ADN Y LAS PROTEÍNAS
 EXPRESIÓN GÉNICA
EXPRESIÓN GÉNICA
EXPRESIÓN GÉNICA
EXPRESIÓN GÉNICA
9 DIAGNÓSTICO
Expresión génica en muestras de mucosa intestinal
En porcino, la expresión génica se ha evaluado de forma sistemática en muestras de mucosa intestinal, principalmente yeyuno, dado que permite obtener una información precisa del tramo del intestino en el que se están produciendo los cambios.
Expresión génica en heces
Recientemente se ha comenzado a realizar una valoración de la expresión génica de marcadores intestinales en las heces de los animales, siendo esta muestra más heterogénea y proporcionando una información más global de los cambios ocurridos a lo largo del tracto digestivo en relación con la integridad y la inflamación intestinal, sin necesidad de sacrificar a los animales para la toma de muestras.


La evaluación de la expresión génica en heces y mucosa intestinal puede realizarse mediante dos tecnologías diferentes:
Transcriptómica: consiste en la secuenciación de todo el ARN mensajero producido por las células de la muestra en cuestión.
Proporciona una imagen completa de los genes que se están expresando en la misma.
La principal limitación de esta técnica es su elevado coste y la necesidad de disponer de equipamiento y personal muy especializados para poder analizar e interpretar todos los resultados obtenidos, dado que se genera una gran cantidad de información.
Cuantificación de la expresión de genes de interés: consiste en la cuantificación del ARN mensajero de genes diana que están involucrados en la salud intestinal mediante la técnica de PCR a tiempo real.

SALUD INTESTINAL Monitorización de la salud intestinal en producción porcina: Biomarcadores y aplicaciones 10 Nº 8 | Julio 2023
En la Tabla 2 se incluyen los principales biomarcadores a monitorizar en producción porcina.
Monitorización Biomarcador Interpretación
Ocludina
Integridad intestinal
Proteína transmembrana de unión estrecha responsable de mantener la unión entre los enterocitos.
Inflamación intestinal
Zonulina-1
Proteína intracelular de unión estrecha responsable de mantener la unión entre los enterocitos.
TABLA 2
IFN-γ
Citoquina proinflamatoria muy relevante en la estimulación de la respuesta inmune inflamatoria.
TGF-β
Calprotectina
Citoquina con función reguladora sobre la respuesta inmunitaria, inhibiendo la síntesis de citoquinas y las funciones de determinadas células inflamatorias.
Proteína inflamatoria con propiedades antimicrobianas producida por los neutrófilos.

Principales biomarcadores para la monitorización de la integridad y la inflamación intestinal en mucosa intestinal y en heces en producción porcina mediante la evaluación de la expresión génica.

11 DIAGNÓSTICO
ABORDAJE DE LA MICROBIOTA INTESTINAL
Una composición óptima de la microbiota intestinal es fundamental para el mantenimiento de una buena salud digestiva. Aunque el componente más conocido y estudiado de la misma son las bacterias, la microbiota también está compuesta por otros microorganismos, como virus, protozoos, arqueas y hongos.
Entre las funciones que desempeña la microbiota intestinal se incluyen: La digestión de ciertos nutrientes.
La producción de compuestos beneficiosos para el organismo como vitaminas o ácidos grasos volátiles.
Funciones inmunitarias indispensables para el correcto funcionamiento del organismo al estimular las células inflamatorias presentes en la lámina propia de la pared intestinal.
En esta microbiota no solo nos encontramos microorganismos beneficiosos, sino que también existen otros perjudiciales, presentes en bajas concentraciones, cuyo incremento puede provocar disbiosis, es decir, desequilibrios en las proporciones de los componentes de la microbiota, lo que a menudo suele traducirse en procesos digestivos, como diarreas.
ES NECESARIO DISPONER DE HERRAMIENTAS QUE PERMITAN ANALIZAR LA MICROBIOTA INTESTINAL DE LOS ANIMALES DE FORMA RÁPIDA Y ECONÓMICA
En producción porcina, el estudio de la microbiota intestinal suele realizarse en muestras de heces, por la facilidad para su recogida y porque no implica el sacrificio del animal. No obstante, también puede evaluarse en muestras de contenido intestinal o, incluso, en la mucosa digestiva.
En la actualidad existen tres abordajes principales para el estudio de la microbiota intestinal:
Metagenómica: consiste en la secuenciación de todo el material genético presente en la muestra, incluyendo no solo bacterias, sino también otros microorganismos.
Aporta una información muy completa, pues además de la taxonomía, también indica la presencia de factores de virulencia o genes de resistencia a antibióticos.
Al igual que en la transcriptómica, sus principales limitaciones son su elevado coste y la necesidad de equipamiento y personal especializados.
Secuenciación masiva del gen 16S ARNr: se trata del estudio de la composición bacteriana de la microbiota intestinal.

Permite cuantificar cada taxón bacteriano, así como las proporciones en las que están presentes y su diversidad.
Cuantificación de taxones bacterianos específicos: consiste en la cuantificación de taxones bacterianos beneficiosos y perjudiciales para la salud digestiva en el cerdo mediante el empleo de la PCR a tiempo real.
De esta manera se realiza una búsqueda dirigida de taxones, simplificando la interpretación de los resultados y reduciendo costes.
SALUD INTESTINAL Monitorización de la salud intestinal en producción porcina: Biomarcadores y aplicaciones 12 Nº 8 | Julio 2023
En la Tabla 3 se incluyen los principales taxones bacterianos a monitorizar en producción porcina.
Técnica Interpretación
Enterobacteriaceae
Familia bacteriana que incluye algunas de las especies bacterianas más perjudiciales para la salud digestiva, como Escherichia coli o Salmonella enterica.

Género bacteriano beneficioso
Participa en la producción de determinados compuestos, como ácidos grasos de cadena corta.
Lactobacillus
Bifidobacterium
Promueve el desarrollo del sistema inmunitario.
Algunas cepas son probióticas.
Género bacteriano beneficioso
Participa en la producción de determinados compuestos, como ácidos grasos de cadena corta.
Promueve el desarrollo del sistema inmunitario.
Algunas cepas son probióticas.
Familia bacteriana beneficiosa por su papel en la digestión de la fibra alimentaria y la producción de ácido butírico.
Lachnospiraceae
Algunos géneros, como Blautia o Roseburia, son muy importantes en el control de los procesos inflamatorios en el intestino.
Familia bacteriana beneficiosa por su papel en la digestión de la fibra alimentaria y la producción de ácido butírico.
Ruminococcaceae
Algunas especies, como Faecalibacterium prausnitzii, tienen un marcado carácter probiótico.
TABLA 3
Taxones bacterianos de interés para la monitorización de la salud intestinal en producción porcina.
13 DIAGNÓSTICO
Técnica
Aplicación Ventajas Limitaciones
Transcriptómica
Imagen completa de los genes que se están expresando en las células de la muestra.
Cuantificación de la expresión de genes de interés
Estudios de la integridad y la inflamación intestinal
Abordaje más específico centrado en la salud intestinal.
Elevado coste. Necesidad de equipamiento y personal muy especializados.
Al ser dirigido, puede que no se detecten los cambios porque se estén produciendo modificaciones en la expresión de otros potenciales genes diana.
Metagenómica
Información muy completa (taxonomía, factores de virulencia y genes de resistencia a antibióticos).

Elevado coste. Necesidad de equipamiento y personal especializados. Secuenciación masiva del gen16S ARNr
Estudio de la microbiota intestinal.
Cuantificación de taxones bacterianos específicos
Cuantificación de cada taxón bacteriano, incluyendo proporciones y diversidad.
Búsqueda dirigida de taxones.
Interpretación sencilla.
Coste reducido.
Información limitada a unos pocos taxones. No se observa la imagen completa de la microbiota.
Posibilidad de sustitución de la funcionalidad entre taxones.
TABLA 4
Resumen de los principales abordajes empleados para evaluar la salud intestinal de los cerdos y sus posibles aplicaciones.
SALUD INTESTINAL Monitorización de la salud intestinal en producción porcina: Biomarcadores y aplicaciones 14 Nº 8 | Julio 2023
¿CÓMO PODEMOS
EMPLEAR EL ESTUDIO DE LA SALUD INTESTINAL EN LA PRÁCTICA VETERINARIA?
Aunque a priori podría parecer que estos estudios están alejados de la práctica diaria en el campo, estas herramientas permiten evaluar de forma objetiva cómo influyen en la salud digestiva de los animales las intervenciones realizadas en la granja, como un cambio de estrategia nutricional, la suplementación con aditivos o, incluso, modificaciones en el manejo y en las instalaciones. Todo ello siempre deberá acompañarse de una evaluación de los parámetros productivos, demostrando la eficacia práctica de las medidas implementadas.
De esta manera se pueden tomar decisiones a corto o medio plazo encaminadas a mejorar el bienestar y la salud digestiva del ganado porcino, garantizando así una salud general y unos rendimientos productivos óptimos.
BIBLIOGRAFÍA
Fouhse, J. M., Zijlstra, R. T., & Willing, B. P. (2016). The role of gut microbiota in the health and disease of pigs. Animal Frontiers, 6(3), 30–36. https://doi.org/10.2527/ AF.2016-0031
Kim, S. W., & Duarte, M. E. (2021). Understanding intestinal health in nursery pigs and the relevant nutritional strategies. Animal Bioscience, 34(3), 338. https://doi. org/10.5713/AB.21.0010


Kwak, M. J., Tan, P. L., Oh, J. K., Chae, K. S., Kim, J., Kim, S. H., Eun, J. S., Chee, S. W., Kang, D. K., Kim, S. H., & Whang, K. Y. (2021). The effects of multispecies probiotic formulations on growth performance, hepatic metabolism, intestinal integrity and fecal microbiota in growing-finishing pigs. Animal Feed Science and Technology, 274, 114833. https://doi.org/10.1016/J.ANIFEEDSCI.2021.114833
Lin, A., Yan, X., Wang, H., Su, Y., & Zhu, W. (2022). Effects of lactic acid bacteria-fermented formula milk supplementation on ileal microbiota, transcriptomic profile, and mucosal immunity in weaned piglets. Journal of Animal Science and Biotechnology, 13(1), 113. https://doi.org/10.1186/S40104-022-00762-8/TABLES/4
Liu, Y. (2015). Fatty acids, inflammation and intestinal health in pigs. Journal of Animal Science and Biotechnology, 6(1), 1–9. https://doi.org/10.1186/S40104-0150040-1/FIGURES/1
Peng, J., Tang, Y., Huang, Y. (2021). Gut health: The results of microbial and mucosal inmune interactions in pigs. Animal Nutrition, 7, 282-294.
Pu, J., Chen, D., Tian, G., He, J., Zheng, P., Mao, X., Yu, J., Huang, Z., Luo, J., Luo, Y., & Yu, B. (2020). Effects of benzoic acid, Bacillus coagulans and oregano oil combined supplementation on growth performance, immune status and
intestinal barrier integrity of weaned piglets. Animal Nutrition, 6(2), 152–159. https://doi.org/10.1016/J. ANINU.2020.02.004
15 DIAGNÓSTICO
V VACUNACIÓN SIMULTÁNEA CON MÚLTIPLES ANTÍGENOS:

¿SON COMPATIBLES EFICACIA Y FACILIDAD DE MANEJO?
MSD Animal Health
n los últimos años, el sector porcino español se ha convertido en uno de los referentes a nivel mundial, tanto a nivel cuantitativo como cualitativo. Aun así, son muchos los desafíos a los que últimamente, tanto productores como veterinarios, debemos enfrentarnos, y que están generando cambios en la manera de afrontar la gestión productiva y sanitaria de nuestras granjas. Algunos de estos retos son más generalistas: medioambientales, sociales, de comunicación… Sin embargo, otros afectan directamente al día a día de las granjas, como son los retos sanitarios y de manejo.
EE
M. Jiménez, M. Marcos y R. Menjón Servicio Técnico Porcino
Nº 8 | Julio 2023 VACUNACIÓN Vacunación simultánea con múltiples antígenos: ¿son compatibles eficacia y facilidad de manejo? 16
Descarga el PDF
LOS RETOS SANITARIOS DE LA PRODUCCIÓN PORCINA MODERNA
En lo referente a la sanidad, estamos viviendo un empeoramiento significativo de la misma y las razones son varias: menor uso de antibióticos, retirada del óxido de zinc, aparición de cepas de PRRS de alta patogenicidad, etc.

El aumento de la prevalencia de diferentes patologías, junto con el compromiso de reducción de uso de antibióticos, hace que la prevención cobre más fuerza en los planes de control sanitario: cada vez vacunamos más y frente a más antígenos. Sin embargo, este abordaje sanitario en ocasiones entra en conflicto con otro de los desafíos reales del sector:
1 2
La complejidad del manejo.
La falta de mano de obra.
Es innegable que la disponibilidad de personal cualificado, así como la retención de este, es un limitante en las granjas, tanto que, en ocasiones, la facilidad de manejo y el ahorro de tiempo es uno de los factores de decisión principales a la hora de implementar medidas sanitarias.
Precisamente por este motivo, uno de los objetivos de MSD Animal Health es ofrecer soluciones tecnológicamente innovadoras que faciliten el manejo de las vacunas, asegurando la eficacia y rentabilidad de las mismas.
APLICACIÓN COMBINADA DE DIFERENTES VACUNAS
La aplicación combinada o simultánea de diferentes vacunas ofrece múltiples ventajas, como:
La reducción de mano de obra y el tiempo de aplicación.
La reducción de manipulaciones y del estrés relacionado con la vacunación.
Mientras que en otras especies la vacunación simultánea con varios antígenos es una práctica habitual, en el sector porcino no lo es tanto. Tradicionalmente, este uso quedaba limitado a vacunas aplicadas en cerdas, como las vacunas bivalentes frente a Parvovirus porcino y Mal Rojo, o frente a E. coli y C. perfringens.
Algunos ejemplos son:
La vacuna de cerdas Porcilis® Ery+Parvo+Lepto
Única vacuna octavalente registrada en Europa para el control de Parvovirus porcino, Mal Rojo y 6 serogrupos de Leptospira
ESTA ES UNA TENDENCIA QUE HA
IDO CAMBIANDO EN LOS ÚLTIMOS AÑOS, AMPLIÁNDOSE
LOS REGISTROS DE VACUNAS COMBINADAS “READY TO USE”, TANTO EN CERDAS COMO EN LECHONES
La vacuna para lechones Porcilis® PCV M Hyo
Primera vacuna bivalente en un solo vial y lista para ser usada registrada en Europa frente a Circovirus porcino tipo 2 y Mycoplasma hyopneumoniae.
V
SANIDAD 17
En otras ocasiones se trabaja en registros de aplicación simultánea de diferentes vacunas ya disponibles, para facilitar la conveniencia y la flexibilidad de los diferentes planes vacunales.
Este es el caso de las vacunas Porcilis® PCV M Hyo, Porcilis® Lawsonia y Porcilis® PRRS que tienen registro específico para administrarse en el mismo momento1
Este tipo de registros facilitan mucho el manejo, puesto que, de manera sencilla, siempre y cuando la dinámica de infección específica de la granja lo permita, en un único manejo puede inmunizarse al lechón frente a cuatro antígenos diferentes, con la evidente reducción de tiempo y mano de obra que ello conlleva.
Ahora bien, la facilidad de manejo nunca debe sacrificar aspectos como la eficacia o la seguridad.
Por tanto, es imprescindible asegurar que la respuesta inmunitaria inducida al aplicar varios antígenos a la vez es, por lo menos, igual que cuando se aplican de manera independiente.
PARA DEMOSTRARLO, SE REALIZAN PRUEBAS DE EFICACIA EN LAS QUE, TRAS ESTUDIOS DE DESAFÍO, SE DEMUESTRA
LA AUSENCIA DE INTERFERENCIA ENTRE VACUNAS
Este es el caso de las vacunas Porcilis® PCV ID, Porcilis® M Hyo ID Dosis Única, Porcilis® Lawsonia ID y Porcilis® PRRS (vía ID) que, recientemente, han obtenido el primer y único registro europeo de administración simultánea de cuatro antígenos aplicados vía intradérmica.
Para demostrar la eficacia y seguridad de este nuevo protocolo vacunal, se realizaron varios estudios de desafío cuyos resultados se publicaron en la revista Animals en 2021 y que resumimos a continuación2
EFICACIA DE LA VACUNACIÓN INTRADÉRMICA SIMULTÁNEA
FRENTE A CIRCOVIRUS PORCINO
TIPO 2, VIRUS PRRS,
MYCOPLASMA HYOPNEUMONIAE Y LAWSONIA INTRACELLULARIS
Horsington, J. et al. (2021) ‘Efficacy of simultaneous intradermal vaccination of swine against porcine circovirus 2, porcine reproductive and respiratory syndrome virus, mycoplasma hyopneumoniae and Lawsonia intracellularis’, Animals, 11(8), p. 2225. doi:10.3390/ ani11082225.

OBJETIVO
ACCEDER AL ARTÍCULO COMPLETO
El objetivo de este estudio fue evaluar la eficacia de la vacunación intradérmica con Porcilis® PCV ID, Porcilis® M Hyo ID Dosis Única, Porcilis® Lawsonia ID y Porcilis® PRRS (vía ID), administradas a la vez y en la misma área anatómica (p. ej. mismo lado del cuello), comparada con la eficacia de las mismas vacunas administradas solas.

Nº 8 | Julio 2023 VACUNACIÓN Vacunación simultánea con múltiples antígenos: ¿son compatibles eficacia y facilidad de manejo? 18
MATERIAL Y MÉTODOS
Lechones de 3 semanas de vida se asignaron a varios grupos de estudio en función del agente infeccioso evaluado:


PCV2
PRRS
Mycoplasma hyopneumoniae (Mhyo)
Lawsonia intracellularis (Law)

En cada grupo de estudio los lechones se dividieron en dos subgrupos:
Grupo 1 (G1)
Lechones vacunados con Porcilis® Lawsonia ID reconstituida en Porcilis® PCV ID y Porcilis® M Hyo Dosis Única, con el dispositivo IDAL 3G Twin
Porcilis® PRRS aplicada con el IDAL 3G Mono Todas las vacunas aplicadas en el mismo lado del cuello del lechón.
Grupo 2 (G2)
Lechones vacunados únicamente con la vacuna correspondiente al grupo de estudio (Porcilis® PCV ID, Porcilis® PRRS, Porcilis® M Hyo Dosis Única o Porcilis® Lawsonia ID respectivamente), administrada con el dispositivo IDAL 3G Mono.
Lechones control sin vacunar.
Tras la vacunación:
1 2
Los diferentes grupos de estudio se desafiaron con el antígeno correspondiente (Tabla 1)
Se definieron diferentes parámetros para cada grupo de estudio en función de la patología de estudio, para evaluar la eficacia de la vacunación (Tabla 2)
+
Grupo 3 (G3)
TABLA 1
Antígeno Semanas post-vacunación PCV2 2 semanas PRRS 4 semanas Mhyo 3 semanas Law 4 semanas
SANIDAD 19
Momento de desafío experimental para los diferentes antígenos.
Antígeno Parámetros evaluados
PCV2
Sintomatología clínica, respuesta inmunitaria humoral, viremia, y presencia vírica en heces y tejidos.
PRRS Sintomatología clínica, fiebre, GMD, respuesta inmunitaria humoral y viremia.
Mhyo Lesiones pulmonares.
Law Sintomatología clínica, GMD, lesiones macro y microscópicas, y carga bacteriana en heces y mucosa del íleon.

RESULTADOS
A continuación, se resumen los resultados más relevantes en cada uno de los grupos de estudio.
Ambos grupos vacunados, con independencia del protocolo (G1 y G2), presentaron una viremia (p<0,0001) (Gráfica 1), carga vírica en heces (p<0,001) y carga vírica en tejidos (p<0,01) significativamente menor en comparación con el grupo control no vacunado. No hubo diferencias significativas entre los grupos de vacunación.
PCV2-G1: PCV ID con Law ID + M Hyo ID + PRRS ID
PCV2-G2: PCV ID
PCV2-G3: no vacunados
GRÁFICA 1
Viremia post-desafío de PCV2 en los tres grupos estudiados (G1, G2 y G3). La flecha señala el momento del desafío.
TABLA 2
Parámetros evaluados en cada grupo en función de la patología estudiada.
PCV2
PCV2
6420- Copias de ADN de PCV2/µl (log 10 ) Día del estudio 0 13 28 35
Nº 8 | Julio 2023 VACUNACIÓN Vacunación
20
simultánea con múltiples antígenos: ¿son compatibles eficacia y facilidad de manejo?
Ambos grupos vacunados, con independencia del protocolo (G1 y G2), presentaron mejor GMD que el grupo control (p<0,0001) y una reducción significativa de la viremia (p<0,0001) (Gráfica 2). De nuevo, los grupos vacunados no presentaron diferencias significativas entre ellos, evidenciando una eficacia equivalente.
PRRS-G1: PCV ID con Law ID + M Hyo ID + PRRS ID
PRRS-G2: PRRS ID
PRRS-G3: no vacunados
GRÁFICA 2
Viremia de PRRS post-desafío en los tres grupos estudiados (G1, G2 y G3). La flecha señala el momento del desafío.
A las 3 semanas post-desafío se observó una reducción significativa de las lesiones pulmonares en ambos grupos vacunales, con respecto al grupo control (p<0,05) (Tabla 3). De nuevo, no hubo diferencias significativas entre los grupos vacunados.
a,bLas puntuaciones con distintos superíndices difieren significativamente entre sí (p < 0,05).
TABLA 3
Puntuación de lesiones pulmonares post-desafío en los tres grupos estudiados (G1, G2 y G3).

hyopneumoniae
PRRS M.
hyopneumoniae
PRRS M.
543210Título de PRRSV (TCID 50 /ml) Día del estudio 0 27 32 35 39 42 49 56 Grupo Puntuación de lesiones pulmonares Mhyo-G1 2,6a Mhyo-G2 0,9a Mhyo-G3 (No vac) 5,2b
SANIDAD 21
Ambos grupos vacunales presentaron reducción de la diarrea, menos carga bacteriana en heces y en la mucosa del íleon, así como una reducción de lesiones, tanto macro como microscópicas, con respecto al grupo control (Tabla 4). De nuevo, sin diferencias entre grupos vacunados.



En todos los casos, los grupos vacunados presentaron mejoras significativas con respecto al grupo control no vacunado.
No hubo diferencias entre los grupos vacunados, confirmando que no hay interferencia entre vacunas o efectos negativos sobre la eficacia cuando se realiza una vacunación simultánea de las vacunas estudiadas.
Estos resultados evidencian que prácticas vacunales que permiten la aplicación de varios antígenos de manera simultánea son beneficiosas, reduciendo el manejo y el estrés asociado a la vacunación, sin afectar negativamente a la eficacia de la vacunación.
Adicionalmente, si la aplicación es intradérmica, se consigue un beneficio adicional sobre el bienestar animal3 que, sin duda, ayudará a mejorar la eficiencia de las granjas.
L. intracellularisL. intracellularis
Diarrea (puntuación) GMD (g/d) qPCR en heces (Log10 pg DNA/µl) Lesiones macroscópicas (puntuación) Law-G1 0,12a 1.074a 0,10a 0a Law-G2 0,08a 1,002a 0,11a 8a Law-G3 (No vac) 2,00b 668 1,18b 109b
BIBLIOGRAFÍA 1.Ficha Técnica Porcilis PCV M Hyo, Porcilis Lawsonia y Porcilis PRRS. 2.Efficacy of Simultaneous Intradermal Vaccination of Swine against Porcine Circovirus 2, Porcine Reproductive and Respiratory Syndrome Virus, Mycoplasma hyopneumoniae and Lawsonia intracellularis. Horsington, J.; Witvliet, M.; Jacobs, A.A.C.; Segers, R.P.A.M. Animals 2021, 11, 2225. 3.Welfare Benefits of Intradermal Vaccination of Piglets. D Temple et al. Animals 2020. TABLA 4
post-desafío
L.
Nº 8 | Julio 2023 VACUNACIÓN Vacunación simultánea con múltiples antígenos: ¿son compatibles eficacia y facilidad de manejo? 22
CONCLUSIÓN
Resultados
de
intracellularis en los grupos estudiados (G1, G2 y G3).
VACUNACIÓN DE FORMA SIMULTÁNEA CON HASTA 4 ANTÍGENOS






L. intracellularis, PCV2, M. hyopneumoniae y PRRS
N U E S T R A I N N O VA C I Ó N , T U C R E C I M I E N T O
Á





N E O D E 4 A N T Í G E N O S
MAXIMIZA
PROTECCIÓN OPTIMIZACIÓN
Lawsonia ID PCV ID PRRS PORCILIS® PRRS PORCILIS® PCV ID PORCILIS®
PORCILIS®
ID
PORCILIS PRRS LIOFILIZADO Y DISOLVENTE PARA SUSPENSIÓN INYECTABLE PARA PORCINO. Liofilizado: Sustancia activa: Virus PRRS cepa DV vivo atenuado: 104,0-106,3 TCID50*. Disolvente: Adyuvante: Acetato Inmunización activa de cerdos clínicamente sanos en un ambiente contaminado con virus de PRRS, para reducir la viremia causada por la infección con cepas europeas del virus de PRRS. Indicaciones específicas: Para cerdos de cebo, el efecto del virus sobre el sistema respiratorio es el más relevante. En las pruebas de campo, los cerdos vacunados, especialmente los lechones vacunados a las 6 semanas de edad, mostraron una mejora significativa de los resultados productivos (reducción de la morbilidad debida a infección con virus de PRRS y mejor crecimiento diario y conversión de pienso) hasta el final del período de cebo. Para cerdos reproductores, el efecto del virus sobre el sistema reproductor es el más relevante. En cerdas vacunadas en ambientes contaminados con el virus de PRRS se observó una mejoría significativa del rendimiento reproductivo y una reducción de la transmisión del virus a través de la placenta después del desafío. El interés de la vacunación con Porcilis PRRS reside en obtener un estado inmune alto y homogéneo frente al virus de PRRS en una explotación. Establecimiento de la inmunidad: 28 días después de la vacunación. Duración de la inmunidad: al menos 24 semanas. No usar en explotaciones donde la prevalencia de virus de PRRS europeo no haya sido establecida mediante Porcilis PRRS debe utilizarse solamente en explotaciones contaminadas con virus de PRRS, donde se haya establecido la prevalencia de virus de PRRS europeo mediante métodos de diagnóstico virológico fiables. No se dispone de datos sobre la seguridad de la vacuna para el rendimiento reproductivo en verracos. No utilizar en explotaciones en las que se haya adoptado un programa de erradicación de PRRS basado en la serología. Vacunar únicamente animales sanos. Precauciones especiales para su uso en animales: Deben tomarse precauciones para evitar la introducción de la cepa vacunal en un área en la que no esté presente el virus de PRRS. El virus vacunal puede transmitirse a cerdos en contacto durante 5 semanas después de la vacunación. La vía de transmisión más común es el contacto directo, pero no puede excluirse la transmisión a través de objetos contaminados o a través del aire. Deben tomarse precauciones para evitar la transmisión del virus vacunal de animales vacunados a animales no vacunados (es decir, cerdas gestantes sin inmunidad) que deben permanecer libres de virus de PRRS. No utilizar en verracos donantes de semen para explotaciones seronegativas, puesto que el virus de PRRS puede ser excretado en el semen durante muchas semanas. Precauciones específicas que debe tomar la persona que administre el medicamento veterinario a los animales: En caso de autoinyección accidental, consulte con un médico inmediatamente y muéstrele el prospecto o la etiqueta. Gestación: Las cerdas adultas y nulíparas sin inmunidad frente a virus de PRRS no deben ser vacunadas durante la gestación, puesto que esto puede tener efectos negativos. La vacunación durante la gestación es segura cuando se lleva a cabo en cerdas adultas y nulíparas ya inmunizadas frente al virus de PRRS europeo mediante la vacunación o por infección de campo. Lactancia: La vacuna puede ser utilizada durante la lactancia. Precauciones especiales de conservación: Vacuna o caja combinada: conservar en nevera (entre 2 °C y 8 °C). Proteger de la luz. Disolvente: conservar a PORCILIS PCV M HYO EMULSIÓN INYECTABLE PARA PORCINO. COMPOSICIÓN POR 2 ml: Sustancias activas: inactivado cepa J ≥ 2,69 UPR2. Adyuvantes: Aceite mineral ligero 0,268 ml, aluminio (como hidróxido) 2,0 mg. 1Unidades antigénicas INDICACIONES. Para la inmunización activa de cerdos, con el fin de reducir la viremia, la carga vírica en pulmones y tejidos linfoides, la excreción del virus causada por la infección con circovirus porcino tipo 2 (PCV2) y la gravedad de las lesiones pulmonares causadas por la infección por Mycoplasma hyopneumoniae. Para reducir la pérdida de ganancia y/o PCV2 (como se observa en estudios de campo). Establecimiento de la inmunidad con vacunación de dosis única: PCV2: 2 semanas : 4 semanas después de la vacunación. Establecimiento de la inmunidad con vacunación de dos dosis: PCV2: 18 días después de la primera vacunación; M. hyopneumoniae: 3 semanas después de la segunda vacunación. Duración de la inmunidad (ambos programas de vacunación): PCV2: 22 semanas después de la (última) vacunación; M. hyopneumoniae: 21 semanas después de la (última) vacunación. CONTRAINDICACIONES: Vacunar únicamente animales sanos. Precauciones específicas que debe tomar la persona que administre el medicamento veterinario a los animales: Al usuario: Este medicamento veterinario contiene aceite mineral. Su inyección accidental/autoinyección puede provocar dolor agudo e inflamación, en particular si se inyecta en una articulación o en un dedo, y en casos excepcionales podría provocar la pérdida del dedo afectado si no se proporciona atención médica urgente. En caso de inyectarse accidentalmente con este medicamento veterinario, consulte urgentemente con un médico, incluso si solo se ha inyectado una cantidad muy pequeña, y lleve el prospecto consigo. Si el dolor persiste más de 12 horas después del examen médico, diríjase de nuevo a un facultativo. Al facultativo: Este medicamento veterinario contiene aceite mineral. Incluso si se han inyectado pequeñas cantidades, la inyección accidental de este medicamento puede causar inflamación intensa, que podría, por ejemplo, terminar en necrosis isquémica e incluso la pérdida del dedo. Es necesaria atención médica experta, INMEDIATA, a cargo de un cirujano, dado que pudiera ser necesario practicar inmediatamente una incisión e irrigar la zona de inyección, especialmente si están afectados los tejidos blandos del dedo o el tendón. Conservar en nevera (entre 2 ºC y 8 ºC). No congelar. Proteger de la luz directa del sol. TIEMPO DE ESPERA: Cero días. Reg. Nº: EU/2/14/175/001-010. Intervet International B.V. PORCILIS LAWSONIA, LIOFILIZADO Y DISOLVENTE PARA EMULSIÓN INYECTABLE PARA PORCINO. COMPOSICIÓN POR DOSIS: Sustancia activa (liofilizado): Lawsonia intracellularis cepa SPAH-08 inactivada ≥ 5323 U*. Adyuvante (disolvente): Aceite mineral ligero 222,4 mg, aluminio (como hidróxido) 2,0 mg. * Unidades de masa antigénica determinadas en el test de potencia in vitro (ELISA). INDICACIONES Para la inmunización activa de cerdos a partir de las 3 semanas de edad para reducir la diarrea, pérdida de ganancia de peso diaria, lesiones intestinales, excreción bacteriana y mortalidad causadas por la infección por Lawsonia intracellularis. Establecimiento de la inmunidad: 4 semanas después de la vacunación. Duración de la inmunidad: 21 semanas después de la vacunación. CONTRAINDICACIONES: Ninguna. PRECAUCIONES: Vacunar únicamente animales sanos. Precauciones específicas que debe tomar la persona que administre el medicamento veterinario a los animales: Al usuario: Este medicamento veterinario contiene aceite mineral. Su inyección accidental/autoinyección puede provocar dolor agudo e inflamación, en particular si se inyecta en una articulación o en un dedo, y en casos excepcionales podría provocar la pérdida del dedo afectado si no se proporciona atención médica urgente. En caso de inyectarse accidentalmente con este medicamento veterinario consulte urgentemente con un médico, incluso si solo se ha inyectado una cantidad muy pequeña, y lleve el prospecto consigo. Si el dolor persiste más de 12 horas después del examen médico, diríjase de nuevo a un facultativo. Al facultativo: Este medicamento veterinario contiene aceite mineral. Incluso si se han inyectado pequeñas cantidades, la inyección accidental de este medicamento veterinario puede causar inflamación intensa, que podría, por ejemplo, terminar en necrosis isquémica e incluso la pérdida del dedo. Es necesaria atención médica experta, INMEDIATA, a cargo de un cirujano, dado que pudiera ser necesario practicar inmediatamente una incisión e irrigar la zona de inyección, especialmente si están afectados los tejidos blandos del dedo o el tendón. No ha quedado demostrada la seguridad del medicamento veterinario durante la gestación o la lactancia. Precauciones especiales de conservación: Liofilizado y disolvente: Conservar en nevera (entre 2 °C y 8 °C). No congelar. Proteger de la luz. TIEMPO DE ESPERA: Cero días. Reg. Nº: 3814 ESP . Merck Sharp & Dohme Animal Health, S.L. fichas
REDUCCIÓN DEL TIEMPO DE MANEJO
LA
DE RECURSOS
M Hyo ID Dosis Única
Lawsonia
Ver
técnicas
Dosis Única
BIOSEGURIDAD VERSATILIDAD FACILIDAD
Descarga el PDF
P CLAVES DEL MANEJO Y ALIMENTACIÓN DEL PORCO CELTA EE
 Manuel Martínez Ruiz Veterinario de ASOPORCEL
Manuel Martínez Ruiz Veterinario de ASOPORCEL

l Porco Celta fue la raza porcina más importante de Galicia hasta mediados del siglo pasado, pero su censo entró en recesión, pasando a estar en peligro de extinción, calificación que conserva hoy en día. No obstante, en los últimos años su censo ha ido en aumento debido a la aceptación por parte de los consumidores y criadores de esta raza.

Nº 8 | Julio 2023 MANEJO Claves del manejo y alimentación del Porco Celta 24
PORCO

CELTA - EL TESORO GALLEGO
El Porco Celta es la única raza porcina autóctona de Galicia, pero su censo ha ido en recesión, llegando a estar en peligro de extinción. Esta pérdida del censo fue debida a dos causas principales:

La intensificación del sector primario y su enfoque durante la segunda mitad del siglo pasado, priorizando la búsqueda de razas de alto nivel de conversión alimentaria sobre las cualidades organolépticas del producto.
1 2 ALIMENTACIÓN
El éxodo rural que sufrió la mayoría del país.
EL INTERÉS EN LA RAZA PORCO CELTA RADICA EN SU IMPORTANCIA COMO PATRIMONIO GENÉTICO, SOCIAL, CULTURAL Y ECONÓMICO, APORTANDO UNAS CANALES CON UNA CALIDAD FÁCILMENTE PERCEPTIBLE
La raza Porco Celta pertenece al tronco celta que, más allá de sus conocidas características morfológicas, se caracteriza por ser animales de tamaño grande y volumen medio, precoces y muy andadores.
Son cerdos de corte rústico muy adaptados a las características climáticas y edafológicas de Galicia, dando como resultado animales resistentes, ideales para mantener en explotaciones extensivas o semiextensivas, es decir, en el sistema de producción tradicional de Galicia.
P
POR PARTE DEL CONSUMIDOR
Para evitar la pérdida de esta emblemática raza, en 1999 se constituyó ASOPORCEL (Asociación de Criadores de la Raza Porcina Celta) que, desde entonces, trabaja en la recuperación y conservación de la raza Porco Celta, siendo la única entidad oficialmente reconocida por la Comunidad Autónoma de Galicia para la gestión del Libro Genealógico de la raza. Afortunadamente, en los últimos años su censo ha ido creciendo debido a la aceptación por parte de los consumidores y criadores de esta raza. 25
MANEJO DEL PORCO CELTA
En la actualidad, el gran grueso del censo de la cabaña del Porco Celta se encuentra en explotaciones reducidas (censo de 4-10 hembras reproductoras), en régimen semiextensivo, regentadas y atendidas por la unidad familiar, de tal forma que se conserva el manejo tradicional de la especie.
Este tipo de manejo se sustenta sobre cuatro pilares de la producción: Genética, Nutrición, Manejo y Sanidad.
MANEJO REPRODUCTIVO
MEJORA GENÉTICA
MEJORA GENÉTICA
Del mismo modo, también se lleva a cabo la calificación por sistema de puntos de la totalidad de los reproductores en una escala del 1 al 10, con el fin de seleccionar aquellos animales con unas características morfológicas deseadas tanto a nivel racial como productivo.

CASTRACIÓN
CASTRACIÓN MONTA NATURAL
MONTA NATURAL
El manejo reproductivo de las explotaciones se basa en la monta natural. Para ello, cuentan con uno o más verracos que realizan la cubrición de las hembras a partir de los 10 meses de edad, llevándose a cabo la manipulación de las fechas de parto mediante el manejo del verraco para llegar al objetivo de 2 partos/año.
El uso de la monta natural como medio reproductivo podría dar a entender que el manejo genético es limitado.

No obstante, al tratarse de explotaciones con un número reducido de hembras, este manejo es viable gracias a la renovación periódica de los machos cuyas líneas genéticas, al igual que las de las hembras, están monitorizadas y tuteladas desde ASOPORCEL que las comprueba mediante el genotipado del 100% de los reproductores y un muestreo de la gran mayoría de las camadas.
ESTA PRÁCTICA PERMITE MANTENER LA CONSANGUINIDAD DE LA CABAÑA A UNOS NIVELES MUY BAJOS, ALGO FUNDAMENTAL EN LA RECUPERACIÓN DE UNA RAZA EN PELIGRO DE EXTINCIÓN
En cuanto al manejo reproductivo en los cebos, se recurre a la castración física de la totalidad de los machos destinados a su engorde y sacrificio, evitando al mismo tiempo sabores indeseados en el producto final.
Igualmente se recurre a la inmunocastración en las hembras para evitar comportamientos indeseados y pérdidas de conversión periódicas fruto de la manifestación del estro.
Nº 8 | Julio 2023 MANEJO Claves del manejo y alimentación del porco celta 26
MANEJO SANITARIO
En lo que respecta a la sanidad animal, en las explotaciones de Porco Celta cuentan con una serie de medidas para lograr la máxima bioseguridad con los recursos disponibles.
Como ya se ha indicado, la mayoría de las explotaciones tienen censos reducidos y, en muchos casos, se realiza la rotación de pastos para evitar la sobrecarga de los mismos.
También cuentan con la ventaja de que, al tratarse de una raza autóctona, los cerdos están sumamente adaptados a las características edafológicas y climáticas de la zona, presentando una mayor resistencia a los agentes externos en comparación con las razas comerciales, así como a patógenos, lo que permite reducir la necesidad de administrar fármacos durante el ciclo productivo.
BIOSEGURIDAD
Desde ASOPORCEL se lleva a cabo un programa sanitario aprobado por la autoridad competente en todas las explotaciones que incluye la vacunación de la cabaña frente a la Enfermedad de Aujeszky, no permitiendo el abandono de esta práctica y logrando la catalogación de indemne de todas las explotaciones a pesar de su régimen extensivo/semiextensivo. Esta vacunación se comprueba mediante estudio serológico en laboratorio acreditado, a la par que se analizan los muestreos para detectar posibles infecciones de Enfermedad de Aujeszky, Peste Porcina Clásica, Peste Porcina Africana, Brucelosis y, en casos de riesgo, Tuberculosis.
Desde el punto de vista de la bioexclusión, las explotaciones cuentan con vallado perimetral electrificado para evitar el contacto con animales silvestres, especialmente con otros suidos.
Cabe destacar que, desde la publicación del Real Decreto 1221/2009, se establece la obligatoriedad de disponer de instalaciones permanentes aisladas del exterior con la capacidad máxima autorizada para poder confinar los animales en caso de necesidad.

27 ALIMENTACIÓN
ALIMENTACIÓN DEL PORCO CELTA
La nutrición y alimentación del Porco Celta está íntimamente asociada al tipo de manejo tradicional de los cerdos.
La gran mayoría de los ejemplares tienen salida al exterior, proveyendo a los ejemplares un contexto donde poder necesidades etológicas y expresar su comportamiento natural. Esto tiene dos consecuencias, por un lado, recorren grandes distancias a lo largo del día, otro lado pastorean, comiendo raíces, tubérculos y pequeños invertebrados.
Pese a que los cerdos son animales monogástricos y no hacen un uso tan eficiente de los nutrientes como los rumiantes, sí que son capaces de hacer un aprovechamiento de los recursos disponibles la fermentación de la celulosa y la hemicelulosa en el ciego y el colon (no así de la lignina).
No obstante, el Porco Celta, aunque pastorea, no solo se desarrolla a base de hierbas y raíces.
Antiguamente, se le suplementaba con restos de comida, granos y harinas, pero hoy en día, los productores han dejado todo eso atrás y les suministran piensos especialmente formulados para las características fisiológicas y de manejo de esta raza, así como para cada etapa de la producción en la que se encuentre el animal.
En las primeras etapas del cebado de los animales, el manejo de la alimentación es muy similar al de cualquier otra raza porcina en el mismo régimen de explotación.

ETAPA DE CRECIMIENTO
La etapa de crecimiento y desarrollo en el Porco Celta es la más delicada desde el punto de vista bromatológico, ya que, al tratarse de una raza de crecimiento muy rápido, gran tamaño y precocidad sexual, se produce una síntesis y depósito de proteínas sumamente alta en un periodo de tiempo muy corto.
Para lograr un soporte óseo adecuado para soportar el peso que alcanzarán al final de su vida productiva y una gran masa magra que aportar tras su sacrificio, es preciso alimentar a los animales durante este periodo de tiempo con una dieta alta en proteínas, vitaminas y minerales de forma equilibrada. Todo ello teniendo en cuenta que, al pastorear, la saciedad de los individuos está condicionada por el volumen ingerido y no fruto de una cobertura de las necesidades nutricionales.
Nº 8 | Julio 2023 MANEJO Claves del manejo y alimentación del Porco Celta 28
ETAPA DE CEBADO
Una vez alcanzada la madurez sexual, se cambia el tipo de ración hacia una formulación distinta, priorizando la calidad de la grasa, ya que la alimentación es uno de los factores que más influencia tiene sobre la calidad de la carne debido a que los lípidos se depositan en los tejidos sin apenas transformación. Por ello, se recurre a una formulación alta en ácido oleico con el fin de obtener un producto más rico en ácidos grasos insaturados, es decir, cardiosaludable.
EL
MANEJO NUTRICIONAL EMPLEADO, EL RÉGIMEN EXTENSIVO QUE PROPORCIONA EJERCICIO A LOS ANIMALES, LAS EDADES DE SACRIFICIO DE LOS CEBOS Y LA GENÉTICA DE LA RAZA TIENEN COMO RESULTADO UNAS CANALES DE UNA CALIDAD SUPERIOR, FÁCILMENTE

PERCEPTIBLE POR EL CONSUMIDOR FINAL
El empleo de Porco Celta dentro del esquema de producción descrito y en régimen de pastoreo tiene otra serie de ventajas:
Al permitir que los animales recorran grandes distancias a lo largo del día, no solo se mejora la calidad, sino que también se minimiza su nivel de estrés, lo que redunda en una mejora de su potencial productivo.
Se produce un aprovechamiento de los recursos naturales producidos in situ con todas las ventajas que ello supone, no solo a nivel económico, sino también a nivel ambiental.
Permite realizar el pastoreo de montes con el ganado haciendo limpieza y desbroce de terrenos abandonados o infrautilizados, siendo una herramienta de lucha contra los incendios forestales, contribuyendo a fijar y mantener población en el medio rural y a compatibilizar la ganadería extensiva con la fauna salvaje.
29 ALIMENTACIÓN
MICOTOXINAS ENEMIGAS INFILTRADAS DE LA SALUD Y LA PRODUCTIVIDAD PORCINA
E
El consumo de piensos contaminados con micotoxinas conlleva importantes riesgos para la salud y productividad porcina. Entre ellas se encuentran las “micotoxinas enmascaradas”, que son difíciles de evaluar mediante técnicas analíticas convencionales, pudiendo pasar desapercibidas en la evaluación rutinaria de los piensos, y las “micotoxinas emergentes”, que no están reguladas legislativamente y que no suelen incluirse en los análisis rutinarios, son una preocupación creciente. Teniendo en cuenta la gran variabilidad en los efectos de las micotoxinas, el problema de las micotoxicosis en los cerdos es bastante complejo, existiendo muchos retos de futuro en este campo de investigación.
Panagiotis Tassis
Profesor
 Titular de Medicina y Reproducción Porcina
Titular de Medicina y Reproducción Porcina
Clínica de Animales de Producción, Facultad
Medicina Veterinaria
Universidad Aristóteles de Tesalónica, Grecia

Nº 8 | Julio 2023 MICOTOXINAS Micotoxinas. Enemigas infiltradas de la salud y la productividad porcina 30
Descarga el PDF
Numerosas micotoxinas, que son metabolitos secundarios de los hongos, afectan a los granos utilizados en la elaboración de piensos para porcino en todo el mundo. Las especies fúngicas productoras de micotoxinas más importantes pertenecen a los géneros Aspergillus, Penicillium, Fusarium, Alternaria y Claviceps1.
MICOTOXINAS - TRIPLE AMENAZA
MICOTOXINAS REGULADAS
Determinadas micotoxinas son consideradas extremadamente relevantes por sus efectos perjudiciales sobre la salud y productividad porcina. Concretamente, se encuadran en este grupo:
Las aflatoxinas (AFs) B1, B2, G1 y G2 (AFB1, AFB2, AFG1 y AFG2).
El deoxinivalenol (DON).
La zearalenona (ZEN).
Las fumonisinas (FBs; FB1, FB2 y FB3).
La ocratoxina A (OTA).
Otras micotoxinas, como la toxina T-2, el nivalenol o los alcaloides ergóticos (o alcaloides del cornezuelo de centeno), se han observado en varios casos en regiones geográficas concretas2

UN ESTUDIO REALIZADO DURANTE UN PERIODO DE 10 AÑOS CON MUESTRAS PROCEDENTES DE 100 PAÍSES REVELÓ QUE DON, FBS Y ZEN ERAN
LAS MÁS PREVALENTES 3
M
PATOLOGÍA 31
Este estudio puso de manifiesto que:
La contaminación de los granos por micotoxinas es un fenómeno mundial, observándose además que las muestras finales de piensos mostraban niveles significativos de contaminación.
La mayoría de las muestras presentaban niveles de contaminación inferiores a los niveles máximos fijados por la UE.
El cambio climático puede aumentar la gravedad del fenómeno de la contaminación de los granos por micotoxinas.
La exposición simultánea a más de una micotoxina en los granos es la “regla” y no la “excepción”.
MICOTOXINAS ENMASCARADAS
Las micotoxinas enmascaradas son metabolitos de fase II modificados biológicamente y formados por mecanismos de defensa de las
El término “micotoxina modificada” abarca todas las formas independientemente de su origen, incluidos los compuestos formados por reacciones a lo largo del procesamiento, por microorganismos o por el metabolismo de


difíciles de evaluar mediante técnicas pudiendo “pasar desapercibidas” en la
Algunas de las micotoxinas modificadas más comunes son:
DON-3-glucósido (D3G), DON (DON3S) y DON (DON15S), ZEN-16-glucósido (ZEN-16G), ZEN-14G, ZEN-14-sulfato.
Nº 8 | Julio 2023 MICOTOXINAS
porcina 32
Micotoxinas. Enemigas infiltradas de la salud y la productividad
MICOTOXINAS EMERGENTES
Las “micotoxinas emergentes”, descritas por primera vez en 20084, son aquellas que no están reguladas legislativamente y que no suelen incluirse en los análisis rutinarios.
Los principales representantes de esta categoría son:
Las enniatinas (ENN).
La beauvericina (BEA).
La moniliformina (MON).
Diversos metabolitos fúngicos, como los precursores de las aflatoxinas (esterigmatocistina, averufina, etc.), alcaloides del cornezuelo del centeno y otros.
BEAUVERICINA
Los efectos tóxicos de la BEA se atribuyen a su estructura molecular que le confiere propiedades ionóforas, actuando como transportador de iones a través de la membrana citoplasmática.
Se ha determinado que esta micotoxina puede tener efectos perjudiciales sobre el rendimiento reproductivo de los cerdos.
BEAUVERICINA ENNIATINAS
ENNIATINAS
Las ENN (ENNB es la más importante) se incorporan a las bicapas lipídicas de las membranas celulares actuando como poros selectivos y aumentando la permeabilidad para los cationes alcalinos.
La rápida metabolización de las ENN explica su baja toxicidad in vivo.

MONILFORMINA
MONILFORMINA
La exposición a MON se asocia a una reducción del peso corporal y de la GMD, así como alteraciones de los valores hematológicos, cardiotoxicidad y mortalidad.
PATOLOGÍA 33
PRINCIPALES EFECTOS DE LAS MICOTOXINAS EN LA SALUD Y LA PRODUCTIVIDAD PORCINA
El consumo de piensos contaminados suele conllevar la ingestión de varias micotoxinas, ya que los granos pueden estar infectados con más de un tipo de hongo y algunas especies de hongos pueden producir más de una micotoxina. A esto se suma el hecho de que la alimentación de los cerdos se compone de mezclas de granos.
LAS PROPIEDADES TÓXICAS DE LAS
PRINCIPALES MICOTOXINAS SE ASOCIAN A UNA GRAN VARIEDAD DE TRASTORNOS PATOLÓGICOS
AFLATOXINAS
Las AFs inhiben la transcripción de ADN a ARNm en el núcleo, reduciendo la síntesis proteica, lo que se traduce en toxicidad y muerte celular. Además, la AFB1 puede suprimir las células presentadoras de antígenos, alterando la función de las células dendríticas y reduciendo la proliferación y diferenciación de los linfocitos T.
Estas micotoxinas afectan, sobre todo, al hígado y al aparato digestivo, aunque también se ha señalado que afectan a los sistemas reproductivo e inmunitario.
En general, reducen la absorción de nutrientes y la ganancia de peso, pero, además, la exposición crónica a dosis bajas provoca ictericia (aspecto pálido-amarillento del hígado) con focos hemorrágicos en el hígado y niveles variables de fibrosis y cirrosis.

Nº 8 | Julio 2023 MICOTOXINAS Micotoxinas. Enemigas infiltradas de la salud y la productividad porcina 34
Adicionalmente, los efectos de las aflatoxinas en el hígado y los riñones influyen en la síntesis del colesterol y, posteriormente, en la activación de la vitamina D, así como en el equilibrio del calcio y el fósforo.
El impacto que tienen las aflatoxinas sobre el hígado se debe al hecho de que este órgano tiene un papel fundamental en su detoxificación En este sentido, las aflatoxinas pueden ser:
Metabolizadas por las enzimas del citocromo P450 del hígado a un epóxido reactivo intermedio que se vuelve más cancerígeno.
Hidroxiladas, produciéndose las aflatoxinas M1 y M2 que son menos dañinas.
LA AFB1 TIENE MAYOR TOXICIDAD Y EFECTOS
CANCERÍGENOS QUE OTRAS AFLATOXINAS

FUMONISINAS
Las fumonisinas se asemejan estructuralmente a la esfingosina (So) y a la esfinganina (Sa), inhibiendo competitivamente a la enzima ceramida sintasa implicada en la conversión de Sa a So y su transformación en esfingolípidos complejos.
Estas micotoxinas provocan alteraciones significativas a nivel del sistema digestivo e inmunitario de los cerdos y, en casos extremos, se puede observar edema pulmonar.
Los signos clínicos asociados a la exposición pueden ser de carácter agudo, subagudo o crónico, pudiéndose observar: Edema pulmonar agudo y mortal (dosis elevadas).
Hepatotoxicosis con ictericia y necrosis hepática (exposición subaguda).
Alteración de la integridad de la barrera intestinal y reducción de la tasa de crecimiento (exposición crónica).
Posibles alteraciones pulmonares crónicas e inmunosupresión (exposición crónica).
Los análisis laboratoriales suelen mostrar:
Lesiones histológicas de edema pulmonar interlobular masivo.
Apoptosis hepática y retención biliar.
Aumento de los niveles séricos de AST, GGT, bilirrubina y colesterol.
PATOLOGÍA 35
IMAGEN 1
IMAGEN 2
A nivel intestinal pueden observarse los efectos de las fumonisinas evidenciados por la fusión y atrofia de las vellosidades intestinales, lo que reduce la capacidad de absorción de nutrientes.



Además, se produce un deterioro de la respuesta inmunitaria local con disminución de la expresión de IL-8 e IL-12p40, produciéndose:
Una disminución de la resistencia eléctrica transepitelial (TEER), de la densidad de células caliciformes y de la presencia de proteínas de unión estrecha (principalmente ocludina y E-cadherina).
Aumento de la translocación bacteriana a otros órganos y proliferación de bacterias oportunistas intestinales debido al aumento de los espacios intercelulares y de la permeabilidad intestinal.
Pulmón de cerdo afectado por la exposición a fumonisinas.
Hígado de cerdo afectado por la exposición a fumonisinas.
Nº 8 | Julio 2023 MICOTOXINAS Micotoxinas. Enemigas infiltradas de la salud y la productividad porcina 36
IMAGEN 3
Alteración de las vellosidades intestinales del íleon por exposición a fumonisinas.
ZEARALENONA
La zearalenona es reconocida por su marcado tropismo hacia el sistema reproductor.
Atraviesa las membranas celulares (p. ej. células uterinas), uniéndose a los receptores citosólicos de E2 (estradiol 17b) y formando un complejo receptor ZEN-E2 (ZEN-E2R) Este complejo pasa al núcleo celular y se une a los receptores nucleares específicos de E2, lo que impide la formación del complejo hormona-receptor.
Como consecuencia, se produce la activación del gen responsable de la síntesis de ARNm (generalmente estimulada por E2), aumentando la actividad de la ARN polimerasa y de la síntesis de proteínas uterinas inducidas por estrógenos, lo que se traduce en efectos anabólicos y reproductores similares a los inducidos por estrógenos.
Estos efectos “estrogénicos” se manifiestan en la forma de:
Pseudogestación.
Reducción de la fertilidad. Síndrome de hiperestrogenismo.


Reducción del tamaño de las camadas.
Aumento del intervalo destetecelo (IDC), etc.
PATOLOGÍA 37
La especie porcina es muy sensible a la ZEN y la toxina parental se metaboliza, principalmente, a α-zearalenol (α-ZEL) en esta especie, presentando este metabolito una mayor potencia estrogénica que la ZEN.
Las cerdas prepúberes parecen ser un grupo de edad muy sensible a los efectos de la toxina.
OCRATOXINA A
La OTA es un potente inhibidor de la síntesis proteica con propiedades nefrotóxicas, carcinogénicas, teratogénicas, inmunotóxicas y, posiblemente, neurotóxicas.
Ocratoxicosis aguda en cerdos se caracteriza por la afectación renal (nefropatía), mientras que en los casos de ocratoxicosis crónica los primeros signos se presentan en forma de reducción del consumo de pienso y de ganancia de peso, observándose deshidratación, diarrea, poliuria y polidipsia.
DEOXINIVALENOL
El deoxinivalenol se une a la subunidad ribosómica 60S, inhibiendo la síntesis de proteínas y ácidos nucleicos, desencadenando un estrés ribotóxico que conduce a la activación de quinasas, MAPKs y sus vías de señalización.
La exposición a esta micotoxina se asocia con alteraciones digestivas, inmunitarias y reproductivas, siendo frecuente la observación de vómitos y severa afectación de la función epitelial intestinal.
EL CERDO SE CONSIDERA LA ESPECIE MÁS SENSIBLE A LA EXPOSICIÓN AL DON5

Nº 8 | Julio 2023 MICOTOXINAS Micotoxinas. Enemigas infiltradas de la salud y la productividad porcina 38
A nivel intestinal se produce un deterioro de la integridad y función de la barrera intestinal, lo que se traduce en una menor capacidad de absorción de nutrientes, así como una alteración de la respuesta inmunitaria intestinal local, desencadenando y potenciando los fenómenos inflamatorios.

Por ello, los principales signos de toxicosis por DON son de tipo gastrointestinal, observándose:
Malestar abdominal.
Diarrea que podría estar asociada a la inhibición de la actividad del transportador dependiente de sodio-glucosa (SGLT-1).
Vómitos.
Anorexia.
Reducción de la ganancia de peso.
Los efectos del DON sobre la función reproductiva se han evidenciado en diferentes estudios y se ha señalado que se originan en las alteraciones en la maduración de los ovocitos y del desarrollo embrionario, junto con la disminución de la ingesta de alimentos.
Además, se ha observado que:
El DON tiene efectos directos dosis-dependientes sobre la esteroidogénesis y la proliferación de células de la granulosa, afectando a la función ovárica y, en consecuencia, al rendimiento reproductivo en cerdos.
Los ovocitos de cerdas jóvenes son más sensibles que los de cerdas cuando se exponen a DON durante la maduración in vitro.
La exposición a corto plazo a dosis relativamente altas de DON (3 y 5,5 mg/kg pienso) puede perjudicar la reproducción y el desarrollo fetal en animales.
Es importante señalar los fenómenos de coocurrencia del DON y las fumonisinas, tal y como puso de manifiesto un estudio6 que revelaba la existencia de una interacción sinérgica y aditiva entre DON y FB1 a nivel intestinal.
PATOLOGÍA 39
DEOXINIVALENOL + ZEARALENONA EN VERRACOS
DEOXINIVALENOL + ZEARALENONA EN VERRACOS
Recientemente, en un estudio in vitro se ha demostrado que los niveles umbral de DON y ZEN (50,6 μM y 62,8 μM para DON y ZEN, respectivamente) pueden causar un deterioro significativo de la motilidad espermática y afectar a los parámetros morfológicos y de viabilidad del semen de verraco.
En este caso, DON y ZEN demostraron tener efectos tóxicos individuales y combinados sobre el semen de verraco in vitro7
La toxina T-2 interactúa con la peptidil transferasa de la subunidad ribosómica 60S, inhibiendo la síntesis proteica, de ARN y de ADN, induciendo apoptosis y necrosis en algunos tipos celulares, así como peroxidación lipídica, con la consiguiente alteración de la integridad de la membrana celular.
El sistema inmunitario es una de las principales dianas de la toxina T-2, atribuyéndosele una actividad inmunomoduladora dual: estimulación a dosis bajas e inhibición a dosis altas.
Interfiere con la maduración de las células presentadoras de antígenos, alterando los niveles de anticuerpos de proliferación linfocitaria, lo que conduce a una mayor susceptibilidad a las enfermedades infecciosas.

Otros hallazgos relacionados con la exposición a toxina T-2 son: Necrosis y ulceración en el tracto digestivo.
Anorexia.
Leucopenia.
Inhibición de la eritropoyesis.
Efectos reproductivos y teratogénicos: alteración del citoesqueleto de los ovocitos porcinos y efectos inhibitorios sobre la producción de esteroides inducida por IGF-I y FSH en las células de la granulosa.
Nº 8 | Julio 2023 MICOTOXINAS Micotoxinas. Enemigas infiltradas de la salud y la productividad porcina 40
TOXINA T-2
RETOS DE FUTURO PARA HACER FRENTE A LA AMENAZA DE LAS MICOTOXINAS EN LAS EXPLOTACIONES PORCINAS
La amenaza de las micotoxinas en la alimentación porcina sigue siendo un problema mundial que podría intensificarse debido al fenómeno del calentamiento global. Teniendo en cuenta la gran variabilidad en los efectos de las micotoxinas, el problema es bastante complejo, existiendo muchos retos de futuro en este campo de investigación.
Las micotoxinas afectan a la salud, la función reproductiva y el rendimiento del ganado porcino, con importantes repercusiones económicas para el ganadero, debiendo prestarse especial atención a los signos clínicos vagos a largo plazo, así como a los signos relacionados con alteraciones recientes de la alimentación.
Dada la alta probabilidad de exposición a varias micotoxinas simultáneamente, los estudios destinados a identificar e interpretar sus complejas interacciones (efectos sinérgicos, aditivos o antagónicos) in vivo es fundamental.
Otro reto es la necesidad de realizar diagnósticos precisos y a tiempo en el campo.
El muestreo en el momento adecuado de las muestras apropiadas y la selección de técnicas de laboratorio de última generación tienen un efecto significativo en la precisión del diagnóstico y el control de la micotoxicosis en las explotaciones.
BIBLIOGRAFÍA
1. Steyn, P.S. The biosynthesis of mycotoxins. Review de Medecine Veterinaire 1998, 149, 469–478.
2. Streit,
Schatzmayr,
A.; Aprodu, I.; Puel, O.; Oswald, I.P. Current Situation of Mycotoxin Contamination and Cooccurrence in Animal Feed Focus on Europe. Toxins 2012, 4, 788-809.
3. Gruber-Dorninger C, Jenkins T, Schatzmayr G. Global Mycotoxin Occurrence in Feed: A Ten-Year Survey. Toxins. 2019;11:375.
4. Jestoi, M. Emerging Fusarium mycotoxins fusaproliferin, beauvericin, enniatins, and moniliformin − a review. Crit. Rev. Food Sci. Nutr. 2008, 48, 21−49.
5. EFSA (European Food Safety Authority). Opinion of the Scientific Panel on Contaminants in the Food Chain [CONTAM] related to Deoxynivalenol (DON) as undesirable substance in animal feed. The EFSA Journal 2004;73, 1-42.
6. Alassane-Kpembi I, Kolf-Clauw M, Gauthier T, Abrami R, Abiola F a, Oswald IP, et al. New insights into mycotoxin mixtures: The toxicity of low doses of Type B trichothecenes on intestinal epithelial cells is synergistic. Toxicol Appl Pharmacol 2013;272:191–8. doi:10.1016/j.taap.2013.05.023.
7. Tassis, P.D.; Tsakmakidis, I.A.; Nagl, V.; Reisinger, N.; Tzika, E.; Gruber-Dorninger, C.; Michos, I.; Mittas, N.; Basioura, A.; Schatzmayr, D. Individual and Combined In Vitro Effects of Deoxynivalenol and Zearalenone on Boar Semen. Toxins 2020, 12, 495.
La exploración de los mecanismos de acción de las micotoxinas a nivel molecular y celular, así como la investigación de nuevos biomarcadores de exposición son algunos de los retos futuros en el campo del diagnóstico de la micotoxicosis en el ganado porcino. Además, las nuevas estrategias de detoxificación y el desarrollo de productos capaces de inducir la biotransformación de las micotoxinas en formas no tóxicas será de gran ayuda en el campo de la prevención y el control de la micotoxicosis desde un enfoque más personalizado.
E.;
G.; Tassis, P.; Tzika, E.; Marin, D.; Taranu, I.; Tabuc, C.; Nicolau,
41 PATOLOGÍA
PREVENCIÓN DE LA PESTE PORCINA AFRICANA - EVALUACIÓN DE LA BIOSEGURIDAD EXTERNA FRENTE A FAUNA SILVESTRE EN EXPLOTACIONES
PORCINAS INTENSIVAS
Mario Sebastián-Pardo1*,








Eduardo Laguna1, Daniel Hernández2 , José Casanovas 3 , Antonio Carpio1, Saúl JiménezRuiz1,4 , Pelayo Acevedo1, Ludovica Preite1, Jordi Baliellas 5 , Llorenç Ricou6 , Vidal Montoro1, Fernando Escribano7, María José Gens 8 , Andrés Cuenca9, Carmen Teodora Morales Cuenca9, Carlos Martínez-Carrasco10 , Gregorio Mentaberre11 y Joaquín Vicente1
1Instituto de Investigación en Recursos Cinegéticos, IREC (UCLM-CSIC-JCCM);



2Interprofesional del Porcino de Capa Blanca, INTERPORC; 3Cincaporc; 4Grupo de Investigación en Sanidad Animal y Zoonosis (GISAZ), Unidad de Investigación Competitiva ENZOEM, Universidad de Córdoba; 5Grup de Sanejament Porcí; 6Cos
d’Agents Rurals de Lleida, Departament d’Interior, Generalitat de Catalunya; 7CRFS
El Valle, ORTHEM; 8Consejería de Medio
Ambiente, Mar Menor, Universidades e Investigación, Comunidad Autónoma Región de Murcia; 9Consejería de Agua, Agricultura, Ganadería y Pesca, Comunidad Autónoma Región de Murcia;
10Departamento de Sanidad Animal (Facultad de Veterinaria), Universidad de Murcia; 11Departamento de Ciencia
Animal, Universitat de Lleida, Wildlife Ecology & Health






*Mario.Sebastian@uclm.es
as poblaciones de ungulados silvestres han experimentado un crecimiento considerable en los últimos años. Este incremento en el número de individuos, junto a la expansión de su área de distribución, ha favorecido el solapamiento con áreas de producción ganadera y, con ello, el riesgo de interacción con el ganado y la transmisión de enfermedades compartidas.


La ausencia de controles sanitarios en la fauna silvestre puede limitar el éxito de los programas de prevención, control y erradicación de enfermedades infecciosas, y comprometer el futuro del sector.
Entre los ungulados, el jabalí es una de las especies más relevantes debido a la existencia de múltiples patógenos compartidos entre esta especie y el ganado porcino (p. ej., complejo Mycobacterium tuberculosis, el virus de la enfermedad de Aujeszky o el virus de la Peste Porcina Africana) (Gortázar et al., 2007).

LL
Nº 8 | Julio 2023 BIOSEGURIDAD Prevención de
Evaluación
bioseguridad
silvestre en
42
la Peste Porcina Africana -
de la
externa frente a fauna
explotaciones porcinas intensivas
Descarga el PDF
UN GRAVE IMPACTO EN LA SANIDAD DE LAS GANADERÍAS, LA INTERRUPCIÓN DEL COMERCIO INTERNACIONAL DE CERDOS Y SUS PRODUCTOS, Y PÉRDIDAS ECONÓMICAS MASIVAS


Esta enfermedad representa una seria amenaza para los porcicultores de todo el mundo y, en particular, una amenaza para el sector porcino español, mayor productor europeo (junto con Alemania).



PESTE PORCINA AFRICANA 43
INTERACCIONES EPIDEMIÓLOGICAS
Desde un punto de vista sanitario, las interacciones epidemiológicas se definen como aquellas en las que individuos de diferentes especies entran en contacto directa o indirectamente con potencial para transmitirse patógenos (Triguero-Ocaña et al., 2021).

INTERACCIÓN DIRECTA
Una interacción directa se define como aquella en la que individuos de ambas especies coinciden en el mismo espacio a la vez.
INTERACCIÓN INDIRECTA
En la interacción indirecta los animales usan los mismos recursos, pero en distintos momentos.
Ambos tipos de interacción (Imagen 1) son relevantes en la epidemiología de la PPA, pues la evidencia científica apoya que el contacto directo con jabalíes y el consumo de alimentos contaminados son las principales vías de infección del cerdo doméstico con el virus.
IMAGEN 1
Interacción indirecta (izquierda) y directa (derecha) entre cerdos domésticos y jabalíes. Fotos: Dragan Gaçic (interacción indirecta), Eduardo Laguna Fernández y Dragan Gaçic (interacción directa).
Los estudios previos de las interacciones entre la fauna silvestre y el ganado porcino ponen de manifiesto una mayor frecuencia y relevancia epidemiológica de las interacciones indirectas sobre las directas en situaciones de producción extensiva (Carrasco-Garcia et al., 2016; Kukielka et al., 2013; Triguero-Ocaña et al., 2021). Sin embargo, el estudio de las interacciones entre el jabalí y el ganado porcino, y su prevención, han sido poco estudiados en ambientes de producción intensiva.




Nº 8 | Julio 2023 BIOSEGURIDAD Prevención de la Peste Porcina Africana - Evaluación de la bioseguridad externa frente a fauna silvestre en explotaciones porcinas intensivas 44
INTERACCIONES JABALÍ-GANADO PORCINO EN AMBIENTES INTENSIVOS
Como se aprecia en el mapa del riesgo de interacción (en términos exclusivamente de solapamiento espacial) entre el porcino doméstico y el jabalí, existen zonas donde la producción porcina intensiva tiene un peso importante en la economía regional (p. ej., Aragón, Cataluña o Murcia) con poblaciones importantes de jabalíes (Figura 1)

Por otro lado, el uso del espacio por parte del jabalí en áreas con elevada densidad de explotaciones porcinas intensivas, a partir de la monitorización de individuos provistos de collares
GPS-GSM utilizados por el equipo firmante de este artículo, indica que estos se aproximan y usan los recursos ganaderos (Figura 2)
EN ESTE ESCENARIO, RESULTA CRUCIAL ESTABLECER
PROGRAMAS DE BIOSEGURIDAD
ADECUADOS QUE
PERMITAN REDUCIR
EL RIESGO DE INTERACCIÓN
JABALÍ-PORCINO Y, DE ESTA FORMA, LA TRANSMISIÓN DE ENFERMEDADES

Mapa del solapamiento espacial del número de explotaciones de porcino doméstico y de la abundancia de jabalí (bolsas de caza), a escala municipal. El color verde indica el nivel de menor riesgo y el rojo el de mayor riesgo. Fuente: IREC y Ministerio de Agricultura, ENETWILD-consortium et al. (2021)
Localizaciones de jabalíes marcados con GPS en el entorno de dos de las explotaciones porcinas intensivas incluidas en este estudio. Los círculos verdes son las localizaciones con un margen asociado al error del GPS, las líneas rojas representan el vallado perimetral de las explotaciones y las líneas azules el perímetro de las balsas de purines (Lagunaetal.,2022a)
 FIGURA 1
FIGURA 2
FIGURA 1
FIGURA 2
PESTE PORCINA AFRICANA 45
BIOSEGURIDAD, UNA HERRAMIENTA IMPORTANTE EN LA PREVENCIÓN DE ENFERMEDADES
La bioseguridad puede definirse como el conjunto de medidas físicas y de manejo que se aplican para evitar la entrada y diseminación de un patógeno en una explotación (Alarcón et al., 2021). Estas medidas se pueden dividir en dos bloques: bioseguridad externa y bioseguridad interna.
BIOSEGURIDAD EXTERNA
La bioseguridad externa tiene como objetivo evitar la entrada de un patógeno en la explotación e incluye medidas como:
El vallado perimetral de la explotación.
El control de acceso de vehículos y personas.
El almacenaje y recogida de cadáveres.
El origen controlado de animales, alimento y agua de la explotación.
BIOSEGURIDAD INTERNA
Las medidas de bioseguridad interna engloban aquellas destinadas a evitar que se difunda el patógeno en la explotación una vez que entra. Entre estas medidas se incluyen:
La limpieza, desinfección, desratización y desinsectación (LDDD).
La formación del personal.
El uso de pediluvios al acceder y salir de una nave.
Estos protocolos llevan varios años implementándose en el sector porcino y, tanto las administraciones europea y española (Reglamento (UE) 2016/429; MAPA, 2015) como la comunidad científica (Alarcón et al., 2019; Ribbens et al., 2008; Simon-Grifé et al., 2013), contribuyen constantemente a su desarrollo y mejora. Sin embargo, hay dos aspectos que se deben considerar respecto a la evaluación de la bioseguridad externa que no se encuentran protocolizados en sistemas de producción intensivos:
1 2
La evaluación del riesgo que supone la fauna silvestre (de especial relevancia en el caso del jabalí).
Medidas deficientes de bioseguridad externa e interna se han relacionado con la aparición de enfermedades en explotaciones porcinas, como es el caso del Síndrome Respiratorio y Reproductivo porcino (PRRS) (Silva et al., 2018), la enfermedad de Aujeszky (Martínez-López et al., 2009) o la PPA (Viltrop et al., 2021).
Esto demuestra la necesidad de desarrollar protocolos que evalúen el nivel de bioseguridad de las explotaciones en los que se incluyan una serie de medidas y acciones correctoras encaminadas a reducir el riesgo de aparición y difusión de un agente patógeno en la explotación.
El objetivo de este trabajo es elaborar un protocolo de evaluación de la bioseguridad externa, específico para cada ganadería, frente a fauna silvestre en ganaderías porcinas intensivas de España.
de la Peste Porcina Africana - Evaluación de la bioseguridad externa frente a fauna silvestre en explotaciones porcinas intensivas
DADO QUE EL RIESGO DE TRANSMISIÓN DE PATÓGENOS PROCEDENTES DEL JABALÍ ES REAL, ES NECESARIO ACTUALIZAR ESTOS SISTEMAS DE EVALUACIÓN
Nº 8 | Julio 2023 BIOSEGURIDAD Prevención
El efecto atrayente que ejerce el entorno de la explotación sobre la fauna silvestre. 46
PROTOCOLO DE EVALUACIÓN DE LA BIOSEGURIDAD EXTERNA

FRENTE A FAUNA SILVESTRE EN GANADERÍAS PORCINAS INTENSIVAS
En un artículo anterior publicado en la revista porciSapiens (Laguna et al., 2022b) se describió detalladamente un protocolo para evaluar el riesgo de interacción entre la fauna silvestre y el ganado porcino en sistemas de producción extensiva.


En el presente trabajo se ha realizado una adaptación de dicho protocolo a las condiciones de producción intensiva, de tal forma que pueda ser replicado en el campo durante una auditoría de bioseguridad por cualquier profesional formado.

VER ANEXOS
epidemiológica
cerramientos
Este protocolo cuenta con tres fases:
Antes de la visita.
Durante la visita.
LEER ARTÍCULO “Guía para la aplicación de protocolos de bioseguridad en explotaciones porcinas extensivas” A B C

Tras la visita.
Puntos de riesgo
Ejemplo de informe final
PESTE PORCINA AFRICANA 47
A. ANTES DE LA VISITA
Antes de visitar la explotación, en colaboración con las Administraciones responsables, es necesario recopilar información sobre:
Clasificación zootécnica de la explotación de acuerdo con el Real Decreto 306/2020.
Resultado de la bolsa de caza del coto/s (número de animales abatidos en una temporada, que habitualmente se usa como un indicador de la abundancia de las especies cinegéticas, especialmente en el caso del jabalí) donde se encuentre ubicada la explotación. En caso de no encontrarse dentro de ningún acotado cinegético, se tomarán los resultados del más cercano.

Distancia a otras infraestructuras: vertederos, mataderos, plantas de tratamiento de subproductos, vías públicas o cotos de caza mayor.
Además, es necesario obtener dos mapas de la explotación: Uno en el que se aprecie con detalle el perímetro de la explotación y sus instalaciones.
Otro que permita visualizar el entorno de la explotación en un radio de 2 km.
B. DURANTE LA VISITA
Estos mapas serán de gran importancia para caracterizar la explotación, el manejo del ganado y la identificación de los potenciales puntos de riesgo durante la auditoría, junto al responsable de responder el cuestionario (ver a continuación).
INFORMACIÓN SOBRE BIOSEGURIDAD INTERNA Y EXTERNA
INFORMACIÓN SOBRE BIOSEGURIDAD INTERNA Y EXTERNA

El cuestionario consta de 14 bloques en los que se recopila información completa sobre los principales aspectos relacionados con la bioseguridad externa e interna en explotaciones porcinas intensivas, poniendo especial énfasis en aquellos relacionados con la fauna silvestre. Concretamente, se solicita información sobre:
Ubicación de la explotación
Se pregunta por la distancia a otras explotaciones porcinas, tanto intensivas como extensivas, teniendo en cuenta aquellas que se sitúan en un radio de 10 km.
Además, se valida la información recogida en la fase anterior sobre distancia a vertederos, mataderos, plantas de tratamiento de subproductos, carreteras/vías de ferrocarril y cotos de caza mayor.
Vallado perimetral de la explotación
1 2 BIOSEGURIDAD Prevención de la Peste Porcina Africana - Evaluación de la bioseguridad externa frente a fauna silvestre en explotaciones porcinas intensivas 48
El objetivo es conocer si existe dicho vallado, de qué tipo de vallado se trata y qué porcentaje del perímetro cubre, con qué frecuencia se revisa y en qué estado se encuentra, prestando especial atención a la presencia de roturas o pasos y al estado de los distintos accesos (p. ej., puertas de entrada a la explotación). Nº 8 | Julio 2023
3 4
Vallado de las instalaciones
En el caso de que, por ejemplo, las naves, balsas de agua o depósito de cadáveres tengan su propio vallado, se cumplimenta la misma información que en el apartado anterior.
Gestión cinegética/fauna silvestre
Número de ungulados (concretamente, jabalí, ciervo y corzo) abatidos en el coto, el porcentaje de perímetro limitante con un coto de caza mayor y la frecuencia de avistamiento de diferentes especies de fauna silvestre (tanto de ungulados como de carnívoros).
También se identifica la zona y se registra la época del año con mayor número de avistamientos de jabalí.
Gestión de purines
Se pregunta por la localización del depósito (balsa), la existencia de un plan de gestión de purines, la accesibilidad/permeabilidad para el jabalí al depósito y el tipo y estado del vallado
Caracterización de los recursos naturales en el entorno de la explotación

Se describen los cultivos, masas forestales y puntos de agua que rodean a la explotación, así como la existencia de indicios de presencia de jabalí (huellas, hozaduras, rascaderos en árboles, bañas, excrementos…) y otros ungulados en las inmediaciones del vallado perimetral.
Entrada de animales
Se solicita información sobre el número de explotaciones de origen de los cerdos, si se hace carga única o por separado de los animales, así como el número de entradas anuales.
5
Caracterización de los recursos naturales del interior de la explotación
Consiste en recopilar la misma información que en el punto anterior, considerando aquello que se encuentre dentro del vallado perimetral de la explotación.
Vehículos
Se registra si los vehículos empleados en la explotación atraviesan el vallado perimetral, si hay vehículos de uso compartido dentro y fuera de la explotación, ubicación del muelle de carga/descarga, si diferentes vehículos comparten camino de acceso y la existencia y mantenimiento de los vados/arcos de desinfección.
Agua
Se registra la localización del depósito de agua, el sistema de desinfección y el grado de permeabilidad/accesibilidad para la fauna silvestre de los puntos de agua.
Alimento
La información recabada en este apartado hace referencia al origen del alimento, el estado de los silos, la existencia de un registro de proveedores/ entregas de pienso y el tipo de alimento que se administra en cada fase de producción.
11 8
10 6
PESTE PORCINA AFRICANA 49
7
9
Personal y visitas
En este apartado se plantean cuestiones referentes al consumo de productos porcinos y de caza (jabalí) dentro de la explotación, empleados que trabajan en varias explotaciones y empleados que practican la actividad cinegética.
Además se pregunta sobre el estado del vestuario y pediluvios y la presencia de ropa exclusiva de la explotación para trabajadores, veterinarios y visitas, entre otras.
13 14
Gestión de cadáveres
En este apartado, se registra el sistema de eliminación de cadáveres (de lechones y del resto de animales), accesibilidad de las especies carroñeras a los cadáveres, sistema de almacenaje y/o eliminación de los cadáveres (contenedores, incineración, hidrólisis, etc.) y la temporalidad por mes del número de bajas.
Limpieza, desinfección, desratización y desinsectación
Se pregunta por la existencia de registros y plan de monitorización de LDDD, la contratación de personal específico para realizarla, la presencia de mallas pajareras, cebos para roedores y mallas mosquiteras, y el programa de desinsectación si existe.
EVALUACIÓN DE LOS GANADEROS RECORRIDO A PIE
EVALUACIÓN DE LOS GANADEROS RECORRIDO A PIE
Además, se incluye un listado que recoge 12 medidas con el objetivo de que el encuestado seleccione las cinco que considere más relevantes en materia de bioseguridad, incluyendo además un apartado de autoevaluación del grado de cumplimiento de estas medidas de acuerdo con el RD 306/2020. Estas medidas son:

Vallado perimetral de la finca (aquí se entiende como el vallado de la explotación en sí).
Vallado perimetral de las instalaciones (se refiere al vallado de cada instalación individual como, por ejemplo, el depósito de cadáveres o las naves).
Control de acceso de vehículos.
Control de acceso e higiene del personal.
Sistemas de limpieza, desinfección, desratización y desinsectación.
Gestión de purines (vallado, almacenaje, etc.).
Gestión de cadáveres (retirada, almacenaje, etc.).
Naves de cuarentena.
Origen certificado de la reposición.
Origen certificado del semen.
Origen certificado del alimento.
Tratamiento del agua.
Tras cumplimentar el cuestionario, se realiza un recorrido a pie por todo el exterior de la explotación para evaluar la presencia de indicios de fauna silvestre (sobre todo jabalí) y se visitan los puntos de riesgo previamente identificados. Algunos puntos críticos son:
Vallados: hay que comprobar su estado, la presencia de vegetación en la base, si hay gateras, si está fijado al suelo y si las puertas ajustan bien al suelo. La Ficha de Cerramientos se utiliza para hacer una descripción pormenorizada de los puntos anteriores.
Balsas de purines o agua: si está vallada, se investigan los mismos parámetros que en el vallado. Además, se evalúa la pendiente de la balsa para juzgar si la fauna silvestre puede tener acceso a ella o no.

Depósito de cadáveres: se revisa si está vallado o no y si los carroñeros pueden acceder a los cadáveres.
Silos: se verifica si presentan fugas o restos de alimento en la base.
12
Nº 8 | Julio 2023 BIOSEGURIDAD Prevención de la Peste Porcina Africana - Evaluación de la bioseguridad externa frente a fauna silvestre en explotaciones porcinas intensivas 50
Puntos de riesgo alrededor de la explotación: se deben visitar los puntos de agua cercanos (charcas, acequias, otras aguas estancadas o cursos naturales) para determinar su accesibilidad para la fauna silvestre (vallado, pendiente, presencia de vegetación en la orilla, etc.) y buscar indicios de la presencia de jabalíes. En el caso de las charcas, deberá medirse el diámetro. Los indicios también deben buscarse en zonas boscosas y en los cultivos que rodean a la explotación.
Toda la información sobre los puntos de riesgo, salvo aquella relativa al vallado, se recogerá en la Ficha Puntos de riesgo y se obtendrán a su vez evidencias fotográficas de todos ellos para una mejor caracterización.

Paralelamente, se identificarán todas las instalaciones de la explotación, los accesos, los tipos de vallado, el movimiento de los vehículos, el entorno de la explotación y los puntos de riesgo en las ortofotos.

La Figura 3 muestra un ejemplo de caracterización espacial de una explotación.
Vehículos
Cadáveres
Entrada de animales
Purines
Salida de animales
FIGURA 3
Puntos de riesgo
Baña de jabalí
Fuga cooler
Charca
Vallado
1,8m, torsión simple sobre tierra sin enterrar
2,3m, torsión simple anclado a hormigón
2m, malla plegada sobre muro hormigón
2m, torsión simple sobre hormigón sin enterrar
2m, torsión simple sobre tierra sin enterrar
Instalaciones
Depósito de agua
Filtro+Desinfección agua
Puerta para personal
Puerta para vehículos
Puerta+arco de desinfección
Silos
Caracterización espacial del movimiento de vehículos, puntos de riesgo y otras infraestructuras de una explotación porcina intensiva a partir de la información recopilada en la auditoría de campo.
Almacén
Placas solares
Maternidad
Hidrolizador Balsa purines
Cuarentena
Gestación confirmada
Gestación control
Almacén
PESTE PORCINA AFRICANA 51
Con toda la información recabada durante la entrevista y la visita a la explotación, se elabora una tabla resumen con los principales resultados encontrados (Tabla 1).
PREGUNTA RESPUESTA
Valla o barrera que separe físicamente el perímetro de la finca del exterior Sí
Tipo de valla o barrera (puede haber varias)
Vallado perimetral
Malla de torsión simple de 2,3 m fijada a hormigón, con vegetación alta en la base
Valla plegada con base de hormigón, altura total 2 m
Porcentaje del perímetro vallado 100%
Frecuencia de revisión del vallado perimetral Mensual
Existencia de pasos de jabalí en el vallado perimetral No

Exteriores de la granja en correcto estado de limpieza y mantenimiento No
Accesos siempre cerrados Sí
Accesos impermeables al jabalí No
Cultivos en el entorno de la explotación
Caracterización del entorno de la explotación
Almendro, cereal, frutal, colindantes a la explotación
Zonas forestales en el entorno de la explotación Bosque de ribera a 1.500 m
Puntos de agua en el entorno de la explotación
TABLA 1
Evidencias de presencia de jabalí en el entorno de la explotación
Charca a 450 m, de 125 m de diámetro, sin vallar, accesible a la fauna silvestre en un 20% y con indicios aislados de jabalí Río a 1.500 m
Sí, se encontró una baña de jabalí cerca de la valla oeste y huellas bordeando el perímetro en esa zona
Tabla resumen obtenida tras la encuesta y el recorrido a pie en una explotación (como ejemplo) para el bloque de vallado perimetral de la explotación y caracterización del entorno.
Nº 8 | Julio 2023 BIOSEGURIDAD Prevención de la Peste Porcina Africana - Evaluación de la bioseguridad externa frente a fauna silvestre en explotaciones porcinas intensivas 52
C. DESPUÉS DE LA VISITA
Tras recoger toda la información sobre la explotación y sus puntos críticos, se identifican los factores de riesgo para dicha explotación y se proponen medidas correctoras para mitigarlo (Tabla 2).
FACTOR DE RIESGO MEDIDAS CORRECTORAS
Revisión del vallado mensual
Aumentar la frecuencia de revisión del vallado a semanal y revisar especialmente tras lluvias intensas por si la escorrentía hubiera abierto gateras en el vallado.
Vegetación alta en la base del vallado perimetral (Imagen 2)
Eliminar la vegetación de esta zona, bien por medios mecánicos o químicos.
Instalar una malla metálica bajo la puerta.
Acceso del vallado perimetral permeable al jabalí en la puerta colindante a la balsa de purines (Imagen 3)


Crear una rampa de hormigón debajo de la puerta para tapar el hueco entre la puerta y el suelo.


Sustituir la puerta por una que ajuste al suelo.
Vallado interior sin fijación al suelo (Imagen 4)
Vegetación alta en la base del vallado interior (Imagen 5)
Baña de jabalí cerca de la valla oeste y huellas bordeando el perímetro en esa zona (Imagen 6)
Charca sin vallar a 450 m con indicios de jabalí en las cercanías (Imagen 7)

TABLA 2
Fijar el vallado a una solera de hormigón
Enterrar la parte baja de la malla 30 cm en el suelo.
Eliminar la vegetación de esta zona, bien por medios mecánicos o químicos.

Cubrir la zona con una solera de hormigón.
Incrementar la presión cinegética sobre el jabalí.
Ejemplo de deficiencias encontradas y medidas correctoras propuestas para la explotación anterior.
B
IMAGEN 2
A. Vegetación alta en la base del vallado perimetral. B. Ejemplo de vallado sin vegetación alta.
A
B B
IMAGEN 3
A. Acceso de vallado perimetral que permite que el jabalí entre en el recinto. B. Ejemplo de acceso impermeable al jabalí.
IMAGEN 4
A. Valla interior sin fijar al suelo. B. Ejemplo de valla fijada al suelo.
A PESTE PORCINA AFRICANA 53
A
Instalación de un vallado impermeable a la fauna silvestre (enterrado 30 cm o fijado a una base de hormigón) que impida el acceso por la parte más accesible.
Toda la información obtenida en la auditoría, los puntos de riesgo observados y las medidas correctoras propuestas se recogen, al igual que se hacía para el porcino extensivo, en un informe final junto con un anexo fotográfico que sirve de apoyo a la información recogida durante la auditoría (Figura 4, Anexo).
IMAGEN 5
A. Vegetación alta en la base del vallado interior. B. Ejemplo de vallado sin vegetación alta.
[financiado por el Ministerio de Agricultura, Pesca y Alimentación y cofinanciado con un 80% por el Fondo Europeo Agrícola de Desarrollo Rural y cuenta con un presupuesto total de 363.424,56€
IMAGEN 6
A. Baña de jabalí (flecha verde). B. Rastros encontrados en el entorno de la explotación.
IMAGEN 7
A A A Nº 8 | Julio 2023
A. Charca sin vallar y accesible a la fauna silvestre a 450 m de la explotación. B. Ejemplo de charca debidamente vallada para impedir el acceso de la fauna silvestre.
Vallado de las instalaciones
Recomendaciones de bioseguridad frente a Peste Porcina Africana Vallado perimetral
Sí Tipo de valla o barrera (puede haber varias)
Malla de torsión simple de 2,3 metros fijada a hormigón, con vegetación alta en la base Valla plegada con base de hormigón, altura total 2m Porcentaje del perímetro vallado
Valla o barrera que separe físicamente el perímetro de la finca del exterior


100 Frecuencia de revisión del vallado perimetral Mensual
Existencia de pasos de jabalí en el vallado perimetral No
No Accesos siempre cerrados Sí Accesos impermeables al jabalí
Exteriores de la granja en correcto estado de limpieza y mantenimiento
Caracterización del entorno de la explotación
Caracterización del interior de la explotación
No
Vallado específico de algunas instalaciones Sí, hay un vallado interior que rodea las naves Tipo de vallado Malla de torsión simple de 2 metros sobre hormigón o tierra sin fijar, con vegetación alta en la base Frecuencia de revisión del vallado
Mensual
Existencia de pasos de jabalí en el vallado
No Accesos siempre cerrados Sí Accesos impermeables al jabalí
Cultivos en el entorno de la explotación Almendro, cereal, frutal, colindantes a la explotación Zonas forestales en el entorno de la explotación Bosque de ribera a 1.500 metros
Sí Existencia de camping No
Puntos de agua en el entorno de la explotación

Evidencias de presencia de jabalí en el entorno de la explotación
Cultivos en el interior de la explotación
Charca a 450 metros, de 125 metros de diámetro, sin vallar, accesible a la fauna silvestre en un 20 % (se hallaron huellas de jabalí en las cercanías) Río a 1.500 metros
Sí, se encontró una baña de jabalí cerca de la valla oeste y huellas bordeando el perímetro en esa zona
No
Zonas forestales en el interior de la explotación No Puntos de agua en el interior de la explotación No
Recomendaciones de bioseguridad frente a Peste Porcina Africana 4. Identificación de riesgos y medidas de bioseguridad propuestas Vallado perimetral de la explotación y de las instalaciones
FIGURA 4
RIESGOS: �������� Revisión mensual de vallado: posibilidad de aparición de gateras entre revisiones
del vallado, especialmente tras lluvias torrenciales En este sentido, se ha visto que
escorrentía. �������� Vegetación alta en la base del vallado exterior e interior riesgo de uso de esta zona
el vallado del sector sur podrían aparecer pronto gateras a causa de la
como refugio de fauna silvestre, sobre todo roedores. �������� Acceso del vallado perimetral permeable al jabalí en la puerta colindante con la balsa
incluso jabalíes de pequeño tamaño, entre otros). �������� Vallado interior no fijado al suelo riesgo de que la fauna silvestre lo levante y acceda

de purines posibilidad de acceso de especies simpátricas (roedores, zorros, tejones
al interior de la explotación MEDIDAS PROPUESTAS:Aumentar la frecuencia de revisión del vallado: una revisión semanal de este
permite identificar rápidamente las gateras que puedan aparecer y reparar el
vallado antes de que la fauna silvestre acceda al interior de la explotación
Eliminar la vegetación en la base del vallado: bien por medios mecánicos, bien por
medios químicos Impermeabilizarlazonainferiorde accesopermeable para hacer totalmente eficaz
el vallado perimetral, por ejemplo, instalando una tela metálica creando una rampa
de hormigón debajo de la puerta o sustituyendo la puerta por una que ajuste bien
de hormigón pero no unido a él) o bien enterrándolo en el suelo 30 cm.
al suelo. Instalación de un vallado interior impermeable a la fauna silvestre bien anclándolo
a la solera de hormigón (en algunos puntos este vallado está sobre una superficie
B B B BIOSEGURIDAD Prevención de la Peste Porcina Africana - Evaluación de la bioseguridad externa frente a fauna silvestre en explotaciones porcinas intensivas 54
RECOMENDACIONES DE BIOSEGURIDAD FRENTE A PESTE PORCINA AFRICANA Ganadería X Este informe ha sido desarrollado por el grupo de investigación Sanidad y Biotecnología(SaBio) del Instituto de Investigación Cinegéticos (IREC) de la Universidad de Castilla-La Mancha en colaboración con la Organización Interprofesional Agro limentaria del Porcino de Capa Blanca (INTERPORC) El estudio forma parte del proyecto grupo operativo PREVPA (PROYECTO INNOVADOR CONVSOBREABUNDANCIA: INNOVACIÓN EN BIOSEGURIDAD Y CONTROL DEL JABALÍ PARA PREVENIR LA PESTE PORCINA AFRICANA
Informe de bioseguridad. Se muestran los apartados de descripción de la ganadería y propuesta de medidas. Fuente: GOPREVPA.
Este protocolo contribuye a mejorar la prevención frente a patógenos presentes en la interfaz producción porcina intensiva-fauna silvestre, integrando el conocimiento recopilado en producciones extensivas e intensivas.
El protocolo reconoce cinco tipos de puntos de riesgo para la interacción fauna silvestre-porcino intensivo: vallados, balsas de purines y agua, depósitos de cadáveres, silos y entorno de la explotación (puntos de agua, zonas boscosas y cultivos).
La realización de un recorrido a pie permite validar las respuestas obtenidas en la encuesta y una mejor evaluación de los puntos de riesgo.
Agradecimientos
El protocolo en ganaderías porcinas intensivas se desarrolló dentro de los proyectos “Armonización de los datos poblacionales de la fauna silvestre en España: aplicaciones a la vigilancia sanitaria y control de enfermedades” (Proyectos de I+D+i, PID2019-111699RB-I00, Ministerio de Ciencia e Innovación) y “Proyecto innovador conv-2020 sobre sobreabundancia: innovación en bioseguridad y control del jabalí para prevenir la peste porcina africana [GOPREVPA]” (financiado por el Ministerio de Agricultura, Pesca y Alimentación y cofinanciado con un 80% por el Fondo Europeo Agrícola de Desarrollo Rural). Agradecemos la colaboración de la Comunidad Autónoma de la Región de Murcia, así como el trabajo del grupo operativo PREVPA, especialmente a los miembros de INTERPORC y del IREC. Agradecer también a las empresas colaboradoras y al personal implicado (CINCAPORC, Piensos Costa, CEFUSA y ADESPOLORCA), incluyendo a los veterinarios que colaboraron o participaron en las visitas, y a los ganaderos entrevistados, por su disponibilidad y buena predisposición para la correcta realización de las auditorías de campo.
BIBLIOGRAFÍA
Alarcón, L. V., Allepuz, A., & Mateu, E. (2021). Biosecurity in pig farms: a review. Porcine Health Management 2021 7:1, 7(1), 1–15. https://doi.org/10.1186/S40813-02000181-Z
Alarcón, L. V., Monterubbianesi, M., Perelman, S., Sanguinetti, H. R., Perfumo, C. J., Mateu, E., & Allepuz, A. (2019). Biosecurity assessment of Argentinian pig farms. Preventive Veterinary Medicine, 170, 104637. https://doi. org/10.1016/J.PREVETMED.2019.02.012
Carrasco-Garcia, R., Barasona, J. A., Gortazar, C., Montoro, V., Sanchez-Vizcaino, J. M., & Vicente, J. (2016). Wildlife and livestock use of extensive farm resources in South Central Spain: implications for disease transmission. European Journal of Wildlife Research, 62(1), 65–78. https://doi.org/10.1007/S10344-015-0974-9/FIGURES/3
ENETWILD-consortium, Illanas, S., Fernández‐López, J., Acevedo, P., Apollonio, M., Blanco‐Aguiar, J. A., Brivio, F., Croft, S., Ferroglio, E., Keuling, O., Plis, K., Podgórski, T., Scandura, M., Smith, G. C., Soriguer, R., Šprem, N., Zanet, S., & Vicente, J. (2021). Analysis of wild boar‐domestic pig interface in Europe: spatial overlapping and fine resolution approach in several countries. EFSA Supporting Publications, 18(1). https://doi.org/10.2903/ sp.efsa.2021.EN-1995


Gortázar, C., Ferroglio, E., Höfle, U., Frölich, K., & Vicente, J. (2007). Diseases shared between wildlife and livestock: A European perspective. European Journal of Wildlife Research, 53(4), 241–256. https://doi.org/10.1007/ S10344-007-0098-Y/FIGURES/4
Jiménez-Ruiz, S., Laguna, E., Vicente, J., García-Bocanegra, I., Martínez-Guijosa, J., Cano-Terriza, D., Risalde, M. A., & Acevedo, P. (2022). Characterization and management of interaction risks between livestock and wild ungulates on outdoor pig farms in Spain. Porcine Health Management, 8(1), 1–14. https://doi.org/10.1186/S40813021-00246-7/FIGURES/4
Kukielka, E., Barasona, J. A., Cowie, C. E., Drewe, J. A., Gortazar, C., Cotarelo, I., & Vicente, J. (2013). Spatial and temporal interactions between livestock and wildlife in

South Central Spain assessed by camera traps. Preventive Veterinary Medicine, 112(3–4), 213–221. https:// doi.org/10.1016/J.PREVETMED.2013.08.008
Laguna, E., Acevedo, P., Jiménez-Ruiz, S., Pascual-Rico, R., Escribano, F., Martínez-Carrasco, C., Mentaberre, G., Ricou, L., Sebastián-Pardo, M., Urbani, N., & Vicente, J. (2022). Use of livestock resources by wild boar in the proximity of indoor pig farms. 13th International Symposium on Wild Boar and Other Suids.
Laguna, E., Jiménez-Ruiz, S., Acevedo, P., García-Bocanegra, I., Risalde, M. Á., Cano-Terriza, D., Jiménez-Martín, D., Montoro, V., Sebastián-Pardo, M., & Vicente, J. (2022). Guía para la aplicación de protocolos de bioseguridad en explotaciones porcinas extensivas. PorciSapiens, 6.
Martínez-Guijosa, J., Lima-Barbero, J. F., Acevedo, P., Cano-Terriza, D., Jiménez-Ruiz, S., Barasona, J. Á., Boadella, M., García-Bocanegra, I., Gortázar, C., & Vicente, J. (2021). Description and implementation of an On-farm Wildlife Risk Mitigation Protocol at the wildlife-livestock interface: Tuberculosis in Mediterranean environments. Preventive Veterinary Medicine, 191, 105346. https://doi.org/10.1016/J.PREVETMED.2021.105346
Martínez-López, B., Carpenter, T. E., & Sánchez-Vizcaíno, J. M. (2009). Risk assessment and cost-effectiveness analysis of Aujeszky’s disease virus introduction through breeding and fattening pig movements into Spain. Preventive Veterinary Medicine, 90(1–2), 10–16. https://doi.org/10.1016/J.PREVETMED.2009.03.004
Ministerio de Agricultura Alimentación y Medio Ambiente (MAGRAMA). (2015). Plan estratégico de bioseguridad en explotaciones porcinas. https://www. mapa.gob.es/es/ganaderia/temas/sanidad-animal-higieneganadera/planbsgenexpporcinas13_04_2015_ tcm30-111887.pdf
Real Decreto 306/2020, de 11 de febrero, por el que se establecen normas básicas de ordenación de las granjas porcinas intensivas, y se modifica la normativa básica de ordenación de las explotaciones
de ganado porcino extensivo. Boletín Oficial del Estado, 38, de 13 de febrero de 2020. https://www.boe.es/eli/es/ rd/2020/02/11/306
Reglamento (UE) 2016/429 del Parlamento Europeo y del Consejo de 9 de marzo de 2016 relativo a las enfermedades transmisibles de los animales y por el que se modifican o derogan algunos actos en materia de sanidad animal («Legislación sobre sanidad animal»). Diario Oficial de la Unión Europea, L84, de 31 de marzo de 2016. http://data.europa.eu/eli/reg/2016/429/oj
Ribbens, S., Dewulf, J., Koenen, F., Mintiens, K., De Sadeleer, L., de Kruif, A., & Maes, D. (2008). A survey on biosecurity and management practices in Belgian pig herds. Preventive Veterinary Medicine, 83(3–4), 228–241. https://doi.org/10.1016/J.PREVETMED.2007.07.009
Silva, G. S., Corbellini, L. G., Linhares, D. L. C., Baker, K. L., & Holtkamp, D. J. (2018). Development and validation of a scoring system to assess the relative vulnerability of swine breeding herds to the introduction of PRRS virus. Preventive Veterinary Medicine, 160, 116–122. https://doi. org/10.1016/J.PREVETMED.2018.10.004
Simon-Grifé, M., Martín-Valls, G. E., Vilar-Ares, M. J., García-Bocanegra, I., Martín, M., Mateu, E., & Casal, J. (2013). Biosecurity practices in Spanish pig herds: Perceptions of farmers and veterinarians of the most important biosecurity measures. Preventive Veterinary Medicine, 110(2), 223–231. https://doi.org/10.1016/J. PREVETMED.2012.11.028
Triguero-Ocaña, R., Laguna, E., Jiménez-Ruiz, S., Fernández-López, J., García-Bocanegra, I., Barasona, J. Á., Risalde, M. Á., Montoro, V., Vicente, J., & Acevedo, P. (2021). The wildlife-livestock interface on extensive free-ranging pig farms in central Spain during the “montanera” period. Transboundary and Emerging Diseases, 68(4), 2066–2078. https://doi.org/10.1111/TBED.13854
Viltrop, A., Reimus, K., Niine, T., & Mõtus, K. (2021).
Biosecurity Levels and Farm Characteristics of African Swine Fever Outbreak and Unaffected Farms in Estonia— What Can Be Learned from Them? Animals 2022, Vol. 12, Page 68, 12(1), 68. https://doi.org/10.3390/ANI12010068
55 PESTE PORCINA AFRICANA
CONCLUSIONES
PROTOCOLO DE BIOSEGURIDAD
EXTERNA FRENTE A FAUNA
SILVESTRE- APLICACIÓN Y VALIDACIÓN SOBRE EL TERRENO
Mario Sebastián-Pardo1*, Eduardo Laguna1, Daniel Hernández², José Casanovas³, Antonio Carpio¹, Saúl Jiménez-Ruiz1,4 , Pelayo Acevedo¹, Ludovica Preite¹, Jordi Baliellas⁵, Llorenç Ricou⁶, Vidal Montoro¹, Fernando Escribano7, María José Gens⁸, Andrés Cuenca⁹, Carmen Teodora Morales Cuenca⁹, Carlos Martínez-Carrasco10, Gregorio Mentaberre11 y Joaquín Vicente1
1Instituto de Investigación en Recursos Cinegéticos, IREC (UCLM-CSIC-JCCM); 2Interprofesional del Porcino de Capa Blanca, INTERPORC; 3Cincaporc; 4Grupo de Investigación en Sanidad Animal y Zoonosis (GISAZ), Unidad de Investigación Competitiva ENZOEM, Universidad de Córdoba; 5Grup de Sanejament Porcí; 6Cos d’Agents Rurals de Lleida, Departament d’Interior, Generalitat de Catalunya; 7CRFS El Valle, ORTHEM; 8Consejería de Medio Ambiente, Mar Menor, Universidades e Investigación, Comunidad Autónoma Región de Murcia; 9Consejería de Agua, Agricultura, Ganadería y Pesca, Comunidad Autónoma Región de Murcia; 10Departamento de Sanidad Animal (Facultad de Veterinaria), Universidad de Murcia; 11Departamento de Ciencia Animal, Universitat de Lleida, Wildlife Ecology & Health

B
BIOSEGURIDAD Nº 8 | Julio 2023 Protocolo de bioseguridad externa frente a fauna silvestre - Aplicación y validación sobre el terreno 56
Descarga el PDF
n el marco del proyecto grupo operativo PREVPA (PROYECTO INNOVADOR CONV-2020
SOBRE SOBREABUNDANCIA: INNOVACIÓN EN BIOSEGURIDAD Y CONTROL DEL JABALÍ PARA PREVENIR LA PESTE PORCINA AFRICANA), el protocolo de evaluación de la bioseguridad externa frente a fauna silvestre en ganaderías porcinas intensivas se aplicó en varias explotaciones, incluyendo diferentes fases de producción, en las provincias de Lleida, Huesca, Zaragoza y la Región de Murcia.

APLICACIÓN Y VALIDACIÓN DEL PROTOCOLO SOBRE EL TERRENO
Con el fin de llevar a la práctica el protocolo de evaluación de la bioseguridad externa frente a fauna silvestre en ganaderías porcinas intensivas, se llevaron a cabo auditorías en 40 explotaciones situadas en varias regiones que albergan el 59,15% del censo y el 44,6% de la producción porcina nacional: las provincias de Lleida, Huesca, Zaragoza y la Región de Murcia.
VALLADO PERIMETRAL
El 90% de las explotaciones contaban con vallado perimetral del REGA según lo recogido en RD 306/2020. La mayoría eran de torsión simple de varios tipos (fijada al suelo o no, sobre tierra o sobre hormigón), aunque algunos tramos eran muros de hormigón.
En ninguna valla perimetral se encontraron pasos de jabalí y en el 85,3% de las explotaciones los accesos siempre estuvieron cerrados.
El 50% de los accesos no fueron impermeables para esta especie. Además, en las inmediaciones del 52,5% de las explotaciones se reportaron indicios de ungulados.
B
EE
SANIDAD ANIMAL 57
BALSAS DE PURINES
El 87,5% de las balsas de purines estaban valladas, aunque tan solo en el 5% de ellas el vallado estaba fijado al suelo.
El 52,5% de las balsas se consideraron permeables al jabalí atendiendo al estado del vallado y a la pendiente de la balsa. Además, se pudo evidenciar el uso de estas balsas por parte de los jabalíes, tanto a través de indicios (hozaduras principalmente) como por observación directa (Imagen 1).
IMAGEN 1
GESTIÓN DE CADÁVERES ENTORNO
En todas las explotaciones la gestión de los cadáveres se realizaba a través de un servicio profesional externo, contando la mayoría de las explotaciones con contenedores simples.
Tres explotaciones contaban con cubas de hidrólisis para su manejo, lo que reduce el riesgo de transmisión de patógenos a través de los cadáveres.
SILOS
En el 20% de las explotaciones se reportaron fugas de alimento en los silos.
El 87,5% de las explotaciones se encontraban dentro de un acotado cinegético, donde la media de jabalíes abatidos fue de 1,5±1,7 (0-6) individuos/km2.
El 80% de las explotaciones tenía una zona boscosa en los aledaños (distancia media 294,3±485,4 (0-2000) m) y el 55,0% uno o varios puntos de agua en las proximidades (496,5±667,5 (0-1200) m).

El 60% de los cultivos de las inmediaciones eran de secano (12,5% leñosas, 45,8% herbáceas y 41,7% mixtas) y el 40% restante regadío (37,5% leñosas, 43,8% herbáceas y 18,8% mixtas).
PERSONAL
Durante las visitas se registraron tanto buenas prácticas de bioseguridad como situaciones de riesgo.
El 15% de las explotaciones permitía el consumo de productos cárnicos de origen porcino en el interior (siempre en comedores habilitados).
El 32,5% tenían empleados que trabajaban en distintas explotaciones.
En tan solo el 52,5% de las explotaciones se diferenciaba zona limpia de sucia en el vestuario.
En un 35% de las explotaciones los empleados practicaban la caza
El 87,5% de las explotaciones tenían carteles con las medidas de bioseguridad y ropa exclusiva para las visitas.
El 100% tenían ropa exclusiva para los trabajadores y registro de visitas.
BIOSEGURIDAD Nº 8 | Julio 2023 Protocolo de bioseguridad externa frente a fauna silvestre - Aplicación y validación sobre el terreno 58
A. Hozaduras encontradas en una balsa de purines. B. Jabalí en el interior de una balsa. Fuente: GOPREVPA y Guardería Forestal de Lleida.
AUTOEVALUACIÓN Y MEDIDAS MÁS VALORADAS POR LOS GANADEROS
VALORACIÓN
DE LAS MEDIDAS POR PARTE DE LOS GANADEROS
Vallado perimetral finca
FIGURA 1
MEDIDAS MÁS SELECCIONADAS
Las medidas de bioseguridad más seleccionadas por los ganaderos fueron:
MEDIDAS MENOS SELECCIONADAS
Las medidas de bioseguridad menos seleccionadas por los ganaderos fueron:
La correcta gestión de cadáveres.
El control de acceso e higiene del personal.
Los sistemas de limpieza, desinfección, desratización y desinsectación (LDDD).
El control de acceso de vehículos.
El vallado de las instalaciones.
1 1 2 2 3 3 4 4 5 5
Las naves de cuarentena.
El origen certificado del semen.
El origen certificado del alimento.
El tratamiento del agua.
El origen certificado de la reposición.
Medidas más valoradas por los ganaderos: frecuencia (n) de medidas de bioseguridad de mayor relevancia para los ganaderos en las 40 explotaciones visitadas. Frecuencia de medidas de bioseguridad (n)
35 30 25 20 15 10 5 0
Control
La nota media sobre el cumplimento de las medidas de bioseguridad fue de 7,9±1,1 sobre 10. En cuanto a la valoración de las medidas por parte de los ganaderos, esta se muestra en la (Figura 1)
acceso higiene personal Gestión cadáveres Origen certificado semen
Origen
Tratamiento agua 19 24 27 30 29 16 32 13 2 2 2 7 SANIDAD ANIMAL 59
Vallado
perimetral instalaciones
Sistemas LDDD Naves de cuarentena Origen certificado alimento Control acceso vehículos Gestión purines
certificado reposición
Paralelamente, se consultó a un panel de 16 expertos pertenecientes a varias entidades públicas y privadas sobre la importancia de algunos aspectos para la prevención de riesgos frente a la interacción del ganado porcino con el jabalí (bien los propios animales, bien sus productos o materiales contaminados por ellos).
Las medidas más valoradas por los expertos fueron:
VALORACIÓN DE LOS EXPERTOS SOBRE MEDIDAS DE PREVENCIÓN DE RIESGO 1
2 3 4 5
El vallado perimetral de la explotación.
La gestión del personal.
La abundancia de jabalí.
El control de vehículos.
La LDDD.
VARIAS MEDIDAS COINCIDIERON CON AQUELLAS MÁS SELECCIONADAS POR LOS GANADEROS, LO QUE PONE DE MANIFIESTO LA TRANSMISIÓN DE CONOCIMIENTO ENTRE
LOS EXPERTOS, LAS ADMINISTRACIONES Y EL SECTOR
RECOMENDACIONES DE BIOSEGURIDAD APLICABLES A LA MAYORÍA DE LAS EXPLOTACIONES
A partir del trabajo de campo realizado, se plantean una serie de recomendaciones aplicables a la mayoría de las explotaciones:
Enterrar en el suelo o fijar a una base de hormigón el vallado perimetral de la explotación y, especialmente, el de las balsas de purines.
Ajustar bien al suelo todas las puertas de acceso, evitando que queden huecos por los que pueda entrar la fauna silvestre.
Revisar frecuentemente el vallado perimetral en busca de gateras y otros puntos vulnerables, e incrementar el esfuerzo en las labores de su mantenimiento.
Evitar que los vehículos ajenos a la explotación accedan al interior de esta (dentro del vallado perimetral). En caso de acceso de vehículos, instalar un arco de desinfección y revisar periódicamente su operatividad.
Vigilar que no queden restos de alimento bajo los silos que puedan tener un efecto atrayente para las especies silvestres.
Prohibir el consumo de productos cárnicos de origen porcino en el interior de la explotación.
Crear y mantener una separación de zona limpia/sucia en el vestuario. Hacer un mayor uso de los pediluvios y mantenerlos en buen estado.
CONCLUSIONES
Es necesario incrementar el número de explotaciones intensivas para auditar, particularmente de ciertas tipologías, así como la cobertura geográfica, para tener una visión más completa y representativa de la diversidad en la producción porcina existente en España y su bioseguridad externa.
La mayoría de las explotaciones estudiadas en varias de las zonas con mayor producción intensiva nacional presentaron buena bioseguridad. Sin embargo, aún hay deficiencias que subsanar, como el estado del vallado y algunos aspectos del personal:
Este protocolo puede ayudar a subsanar las deficiencias encontradas y mejorar el nivel de bioseguridad de las explotaciones en las que se aplique.
AGRADECIMIENTOS
El protocolo en ganaderías porcinas intensivas se desarrolló dentro de los proyectos “Armonización de los datos poblacionales de la fauna silvestre en España: aplicaciones a la vigilancia sanitaria y control de enfermedades” (Proyectos de I+D+i, PID2019-111699RB-I00, Ministerio de Ciencia e Innovación) y “Proyecto innovador conv-2020 sobre sobreabundancia: innovación en bioseguridad y control del jabalí para prevenir la peste porcina africana [GOPREVPA]” (financiado por el Ministerio de Agricultura, Pesca y Alimentación y cofinanciado con un 80% por el Fondo Europeo Agrícola de Desarrollo Rural). Agradecemos la colaboración de la Comunidad Autónoma de la Región de Murcia, así como el trabajo del grupo operativo PREVPA, especialmente a los miembros de INTERPORC y del IREC. Agradecer también a las empresas colaboradoras y al personal implicado (CINCAPORC, Piensos Costa, CEFUSA y ADESPOLORCA), incluyendo a los veterinarios que colaboraron o participaron en las visitas, y a los ganaderos entrevistados, por su disponibilidad y buena predisposición para la correcta realización de las auditorías de campo.
BIOSEGURIDAD Nº 8 | Julio 2023 60






El
300 mg/ml Paracetamol 30% ® SOLUCIÓN PARA ADMINISTRACIÓN EN AGUA DE BEBIDA Sin fiebre Sin úlceras Sin dolor +INFO En caso de duda consulte a su veterinario
La edad ya NO importa.
tiempo de espera SÍ.
A ANTIBIÓTICOS Y CARNE: UN ENFOQUE NOVEDOSO EN LOS MÉTODOS DE VIGILANCIA

LL
a ingestión de carne contaminada con residuos de antibióticos puede generar toxicidad directa, reacciones alérgicas y/o disbiosis de la microbiota intestinal, además de contribuir al desarrollo de resistencias a antibióticos, fenómeno que que se considera ya como uno de los diez mayores retos a los que se enfrenta la humanidad en las próximas décadas.

ANTIMICROBIANOS Nº 8 | Julio 2023 Antibióticos y carne: un enfoque novedoso en los métodos de vigilancia 62
Dr. Mª Jesús Serrano Andrés Unizar-IA2
Descarga el PDF
IMPORTANCIA DE LA MONITORIZACIÓN DE RESIDUOS DE ANTIMICROBIANOS EN CARNE

Los antibióticos son herramientas indispensables para salvaguardar la salud humana y animal en el marco One Health. Sin embargo, a pesar de que los últimos datos publicados muestran que en Europa hay un mayor consumo en medicina humana que veterinaria (EFSA, 2021a), su uso está todavía extendido en animales de producción, incluso con fines no terapéuticos (Brown et al., 2017; Diana et al., 2020), generando graves problemas para la salud pública.
La ingestión de carne contaminada con residuos de antibióticos puede generar toxicidad directa, reacciones alérgicas y/o disbiosis de la microbiota intestinal, y dar lugar al incremento de resistencias a antibióticos (AMR) que se pueden acumular en nuestra microbiota intestinal (Wang et al., 2016), fenómeno acrecentado por la liberación al medio ambiente de los residuos antimicrobianos utilizados en las granjas (Hamscher et al., 2005; Sarmah et al., 2006; Zhou et al., 2020), tanto que la OMS (Organización Mundial de la Salud) ya lo considera como uno de los 10 mayores retos a los que se enfrenta la humanidad en las próximas décadas (OMS, 2021).
Un buen control de los tratamientos antimicrobianos en granja es suficiente para evitar su aparición en la carne, lo que, unido al buen hacer de veterinarios y ganaderos, estrategias como las propuestas por la Agencia Europea del Medicamento (EMA, 2020) y una legislación conservadora, han conseguido rebajar la notificación de muestras no-conformes hasta un 0,14% en 2019 en Europa (Agencia Europea de Seguridad Alimentaria EFSA, 2021b). Sin embargo, no existen datos sobre las muestras que contienen residuos de antibióticos por debajo de los LMR (Límites Máximos de Residuos, Reg. 37/2010).
Puesto que España y Francia son los países con la producción cárnica más alta de Europa (Eurostat, 2020), y están entre los mayores consumidores europeos (Kanerva, 2013) e incluso a nivel mundial (FAO, 2021), se planteó un estudio para evaluar la incidencia de residuos antimicrobianos en carne comercializada del área transfronteriza España-Francia (POCTEFA), procedente de cinco de las ciudades más pobladas y diferentes especies animales, y tipificar las tendencias de su aparición mediante un análisis secuencial (mediante método de cribado y confirmatorio, Reg. 2017/625) análogo al propuesto en control oficial.
A
ONE HEALTH 63
MATERIAL Y MÉTODOS
RECOGIDADE MUESTRAS COMERCIALES RECOGIDA DE MUESTRAS COMERCIALES
Se recogieron 5.357 muestras de carne comercial de cinco ciudades:
Zaragoza, Logroño, Bilbao, Perpiñán y Toulouse. El número de muestras por especie y ciudad se recoge en la Tabla 1
TABLA 1
Número y porcentaje de muestras de cada especie recogido en cada ciudad.
Todas las muestras se analizaron de acuerdo a la normativa vigente (Reglamento 2021/808).
Se llevó a cabo un análisis de cribado (Explorer® + QuinoScan®) seguido de un análisis cromatográfico por UHPLC-QTOF (Ultra High Performance Liquid Chromatogrphy - Quadrupole Time of Flight, de aquí en adelante, QTOF) de las muestras sospechosas (positivas a dos análisis de cribado consecutivos) de acuerdo a lo descrito por Serrano et al. (2022).
El test Explorer® es un test de base biológica para el cribado de un amplio espectro de antibióticos, mientras que QuinoScan® detecta específicamente quinolonas, familia para la cual no es sensible Explorer®. El programa GraphPad Prism® (San Diego, California, USA) se utilizó para la representación de resultados y los análisis estadísticos por ANOVA.
Zaragoza Bilbao Logroño Toulouse Perpiñán TOTAL No. % No. % No. % No. % No. % No. % Vacuno 299 25,9 233 24,2 334 26,7 355 34,5 210 21,9 1.431 26,7 Pollo 300 26,0 307 31,9 258 20,6 319 31,0 146 15,2 1.330 24,8 Cerdo 219 19,0 202 21,0 219 17,5 171 16,6 129 13,4 940 17,5 Pavo 109 9,4 112 11,6 103 8,2 77 7,5 152 15,8 553 10,3 Cordero 145 12,6 50 5,2 127 10,2 42 4,1 115 12,0 479 8,9 Conejo 83 7,2 59 6,1 109 8,7 14 1,4 52 5,4 317 5,9 Pato 31 2,5 48 4,7 94 9,8 173 3,2 Caballo 19 1,5 1 0,1 60 6,3 80 1,5 Codorniz 37 3,0 37 0,7 Cabra 11 0,9 11 0,2 Pintada 2 0,2 2 0,2 4 0,1 Perdiz 2 0,2 2 0,04 TOTAL 1.155 100 963 100 1.250 100 1.029 100 960 100 5.357 100
ANTIMICROBIANOS Nº 8 | Julio 2023 Antibióticos y carne: un enfoque novedoso en los métodos de vigilancia 64
RESULTADOS
Resultados del cribado de amplio espectro de antibióticos
La Tabla 2 muestra los resultados del cribado de amplio espectro de antibióticos de las 5.357 muestras de carne comercial, clasificados por especies y ciudades.
Globalmente, el 3,5% de las muestras recogidas resultaron positivas.
Los mayores porcentajes se describieron en aves, mientras que los menores se describieron en vacuno.
Especies con un tamaño muestral pequeño (n ≤ 50) no se consideraron representativas.
ANÁLISIS DE CRIBADO ANÁLISIS DE CRIBADO
Resultados del cribado de quinolonas
Los resultados del cribado de quinolonas se muestran en la Tabla 3, clasificados por especies y ciudades.
En total, el 0,2% de las muestras resultaron positivas a la presencia de quinolonas.
TABLA 2
Número y porcentaje de muestras de cada especie positiva en el cribado de amplio espectro de antibióticos recogidas en cada ciudad (comparadas con el número total de muestras de cada especie recogidas en cada ciudad).
Zaragoza Bilbao Logroño Toulouse Perpiñán TOTAL No. % No. % No. % No. % No. % No. % Vacuno 7 2,3 3 1,3 4 1,2 5 1,4 0 0 19 1,3 Pollo 14 4,7 7 2,3 5 1,9 25 7,8 1 0,7 52 3,9 Cerdo 10 4,6 12 5,9 2 0,9 11 6,4 0 0 35 3,7 Pavo 7 6,4 5 4,5 6 5,8 12 15,6 5 3,3 35 6,3 Cordero 5 3,4 3 6 2 1,6 0 0 1 0,9 11 2,3 Conejo 4 4,8 4 6,8 1 0,9 0 0 3 5,8 12 3,8 Pato 11 35,5 5 10,4 0 0 16 9,2 Caballo 0 0 0 0 2 3,3 2 2,5 Codorniz 0 0 0 0 Cabra 2 18,2 2 18,2 Pintada 1 50 0 0 1 25 Perdiz 0 0 0 0 TOTAL 47 4,1 34 3,5 33 2,6 59 5,7 12 1,3 185 3,5
ONE HEALTH 65
TABLA 3
Número y porcentaje de muestras de cada especie positivas a quinolonas recogidas en cada ciudad (comparadas con el número total de muestras de cada especie recogidas en cada ciudad).

Resultados generales del cribado
Los resultados finales del cribado están representados en la Tabla 4, organizados por especies y ciudades, y son resultado de sumar los resultados del cribado de amplio espectro de antibióticos y los del cribado de quinolonas.
Zaragoza Bilbao Logroño Toulouse Perpiñán TOTAL No. % No. % No. % No. % No. % No. % Vacuno 0 0 0 0 0 0,6 1 0,3 1 0,5 2 0,3 Pollo 0 0 0 0 0 0 0 0 0 0 0 0,0 Cerdo 0 0 0 0 0 0,9 1 0,6 0 0 1 0,3 Pavo 0 0 0 0 0 0 0 0 0 0 0 0,0 Cordero 0 0 0 0 2 1,6 0 0 0 0 2 0,4 Conejo 1 1,2 1 1,7 0 0 0 0 2 3,8 4 1,3 Pato 0 0 0 0 2 2,1 2 1,2 Caballo 0 0 0 0 0 0 0 0,0 Codorniz 0 0 0 0,0 Cabra 0 0 0 0,0 Pintada 0 0 0 0 0 0,0 Perdiz 0 0 0 0,0 TOTAL 1 0,1 1 0,1 2 0,5 2 0,2 5 0,5 11 0,2
ANTIMICROBIANOS Nº 8 | Julio 2023 Antibióticos y carne: un enfoque novedoso en
métodos de vigilancia 66
los
TABLA 4
Número y porcentaje de muestras de cada especie positivas al cribado recogidas en cada ciudad (comparadas con el número total de muestras de cada especie recogidas en cada ciudad).
*Se eliminó una muestra de conejo de Bilbao y otra de Perpiñán porque daban resultado positivo a ambos tests.
Tras el cribado, las 194 muestras positivas se analizaron por UHPLC-QTOF (de aquí en adelante, QTOF).
ANÁLISIS CROMATOGRÁFICOS DE CONFIRMACIÓN
ANÁLISIS
CROMATOGRÁFICOS DE CONFIRMACIÓN
Se confirmó que 30 de ellas (15,2%) contenían residuos (Tabla 5), con la siguiente distribución:
Tetraciclinas (40,6%)
Sulfamidas (37,5%)
Quinolonas (18,8%)
Lincomicina (3,1%)
Zaragoza Bilbao Logroño Toulouse Perpiñán TOTAL No. % No. % No. % No. % No. % No. % Vacuno 7 2,3 3 1,3 4 1,8 6 1,7 1 0,5 21 1,5 Pollo 14 4,7 7 2,3 5 1,9 25 7,8 1 0,7 52 3,9 Cerdo 10 4,6 12 5,9 2 1,8 12 7,0 0 0,0 36 3,8 Pavo 7 6,4 5 4,5 6 5,8 12 15,6 5 3,3 35 6,3 Cordero 5 3,4 3 6,0 4 3,1 0 0,0 1 0,9 13 2,7 Conejo 5 6,0 4* 8,5 1 0,9 0 0,0 4* 9,6 16 5,0 Pato 0 0 11 35,5 5 10,4 2 2,1 18 10,4 Caballo 0 0 0 0,0 0 0,0 2 3,3 2 2,5 Codorniz 0 0 0 0,0 0 0 0 0,0 Cabra 0 0 2 18,2 0 0 2 18,2 Pintada 0 0 0 1 50,0 0 0,0 1 25,0 Perdiz 0 0 0 0,0 0 0 0 0,0 TOTAL 48 4,2 34 3,6 35 2,8 61 5,9 16 1,8 194 3,6
EN TOTAL, 194 MUESTRAS FUERON POSITIVAS AL CRIBADO, LO QUE CORRESPONDE A UN 3,6% DE LAS MUESTRAS RECOGIDAS
ONE HEALTH 67
TABLA 5
Muestras positivas al cribado que contenían residuos de antibióticos (identificadas por QTOF).
Ciudad Especies Antibiótico Concentración (µg/kg)
Cordero Enrofloxacina 218,8
Ciprofloxacina 34,34
No conformes
Logroño
Cabra Sulfadiazina 164,3
Cabra Doxiciclina 813
Toulouse Cerdo Sulfadimetoxina 110
Perpiñán Conejo Sulfadimetoxina 187
Zaragoza Cordero Sulfadiazina 81,89
Bilbao Cordero Sulfadoxine 96,4
Cercanas al LMR
Oxitetraciclina 21,7
Logroño Cordero Sulfadiazina 56,2
Toulouse Cerdo Enrofloxacina 88
Perpiñán Conejo Sulfadimetoxina 80
Pollo Doxiciclina <LoD
Pollo Doxiciclina 25,46
Pollo Doxiciclina <LoD
Cerdo Doxiciclina <LoD
Cerdo Doxiciclina 9,24
Cordero Sulfadiazina 12,4
Conformes
Zaragoza
Cordero Sulfadiazina 14,68
Pavo Doxiciclina <LoD Enrofloxacina 10,42
Pavo Doxiciclina <LoD
Negativas
Conejo Sulfadimetoxina 22,7
Conejo Enrofloxacina 6,84
Bilbao Pollo Lincomicina 3,4
Pavo Doxiciclina 7,05
Conejo Enrofloxacina 39,5
Logroño Pollo Doxiciclina 27,71
Cordero Enrofloxacina 9,7
Pavo Doxiciclina 6,6
Toulouse Pollo Sulfadimetoxina 12,5
Pollo Doxiciclina 31,5
Pavo Sulfadimetoxina <LoD
LoD = Límite de detección
Nº 8 | Julio 2023 Antibióticos y carne: un enfoque novedoso en los métodos de vigilancia 68
ANTIMICROBIANOS
Solamente el 0,093% del total de las muestras recogidas fue no conforme (contenían residuos de antibióticos por encima de los niveles que marca el Reg. 37/2010).
Este valor es incluso mejor que los últimos datos publicados por la Agencia Europea de Seguridad Alimentaria, que declararon un 0,14% de muestras no conformes para 2019 (EFSA, 2021b).
De las 194 muestras positivas, 5 tuvieron concentraciones próximas a los LMR (56-96 μg/kg) y otras 20 presentaron concentraciones muy bajas.
En cambio, en las 164 muestras restantes, no se identificaron residuos de antibióticos.
ESTUDIOS ADICIONALES PARA DETECTAR LAS CAUSAS DE LA DIVERGENCIA ENTRE LOS RESULTADOS DEL CRIBADO Y LA CONFIRMACIÓN CROMATOGRÁFICA
No obstante, existe un amplio gap entre el 3,6% de positivos al cribado y el ~0,1% de positivos a la cromatografía.
Como ambos tests están validados y ajustados a los LMR, no pueden ser responsables de la desviación.
El test de amplio espectro para el cribado de antibióticos, basado en la inhibición del crecimiento de microorganismos sensibles, detectó el mayor porcentaje de positivos del cribado, lo que demuestra la presencia de metabolitos biológicamente activos.
Por su parte, la cromatografía detecta las moléculas diana en una muestra en base a su composición química.
Por ello, se plantearon diversas hipótesis que pudieran explicar la presencia de moléculas inhibitorias del crecimiento bacteriano en el cribado de amplio espectro de antibióticos pero que no son detectables por la cromatografía dirigida.
En un esfuerzo por reducir la administración de antibióticos en ganadería, el uso de sustancias naturales con actividad antibiótica está aumentando. Entre éstas destacan los aceites esenciales, ya que mejoran la salud general de los animales, el rendimiento e incluso la calidad de la carne (Omonijo et al., 2018).
ANTIMICROBIANOS ALTERNATIVOS: ACEITES ESENCIALES
ANTIMICROBIANOS
ALTERNATIVOS: ACEITES ESENCIALES
De hecho, algunos estudios han revelado que pueden acumularse en músculo (de Haro, 2015) y que pueden afectar a la capacidad de germinación y crecimiento de bacterias esporuladas, por ejemplo, de Geobacillus stearothermophilus (Voundi et al., 2015), microorganismo esporulado en el que está basado el test de cribado de amplio espectro de antibióticos.
ONE HEALTH 69
La bioacumulación a nivel muscular de los aceites esenciales añadidos a los piensos podría ser responsable de su inhibición y, por tanto, de las altas tasas de muestras positivas al cribado de amplio espectro de antibióticos que no se confirmaron por QTOF.
Para evaluar lo acertado de esta hipótesis, muestras de carne blanca se doparon con concentraciones conocidas de aceites esenciales y, a pesar de que el carvacrol, orégano y cinamaldehído inhibieron el crecimiento de G. stearothermophilus , dando resultados positivos al cribado de amplio espectro de antibióticos, tal y como se muestra en la Tabla 6, las concentraciones fueron superiores a 200 μL/L, lo que aportaría un olor y sabor tan intenso que resultaría desagradable. Por ello, se descartaron como responsables de la elevada positividad del cribado vs QTOF.
PRESENCIA DE METABOLITOS BIOLÓGICAMENTE ACTIVOS
PRESENCIA DE METABOLITOS
1Análisis confirmatorios de residuos antibióticos en muestras aleatorias negativas al cribado
De entre las muestras de carne comercial negativas al test de cribado, se tomaron 138 de forma aleatoria y se analizaron por QTOF para comprobar la presencia de trazas de antibióticos entre las muestras negativas y corroborar el buen funcionamiento de los tests, ya validados.

Tal y como muestra la Tabla 7, 17 de las 138 muestras (12,3%) contenían residuos de antibióticos siempre por debajo de los LMRs (no se encontraron falsos negativos, es decir, todas ellas eran conformes, lo que corrobora el buen funcionamiento del método de cribado).
PROCEDENTES DE LA DEGRADACIÓN DE LOS ANTIBIÓTICOS
BIOLÓGICAMENTE ACTIVOS PROCEDENTES DE LA DEGRADACIÓN DE LOS ANTIBIÓTICOS
ORIGINALMENTE PRESENTES EN MÚSCULO
ORIGINALMENTE PRESENTES EN MÚSCULO
LA FAMILIA MÁS DETECTADA FUERON
LAS TETRACICLINAS
(63,2% DE LAS MUESTRAS CON RESIDUOS), SEGUIDA POR
LAS QUINOLONAS (15,8%), LINCOMICINA (10,5%)
Y SULFAMIDAS Y ß-LACTÁMICOS (5.3% PARA CADA UNA DE ELLAS)
La diferencia entre el porcentaje de muestras positivas al cribado que contenía residuos de antibióticos identificados por QTOF (15,5%) y el porcentaje de muestras negativas al cribado que contenían estos residuos analizados por el mismo método (12,3%), fue del 3,2%.
Este valor es muy próximo al porcentaje de muestras positivas al cribado, excluyendo aquellas que fueron no-conformes (5 muestras) y aquellas conformes próximas al LMR (5 muestras), que resulta en un 2,4% (184 de 5.357).
Las muestras adicionales positivas al cribado y con trazas de antibióticos podrían contener metabolitos biológicamente activos derivados del compuesto original. Así, tanto los antibióticos originales como sus metabolitos, que pasarían inadvertidos para la cromatografía dirigida, serían responsables de la inhibición observada en el cribado.
No obstante, aunque estos resultados apoyan la hipótesis de la presencia de metabolitos biológicamente activos, fue necesario llevar a cabo experimentos adicionales para demostrar su presencia.
ANTIMICROBIANOS Nº 8 | Julio 2023 Antibióticos y carne: un enfoque novedoso en los métodos de vigilancia 70
2Presencia en carne de metabolitos biológicamente activos derivados de los antibióticos originales
En el caso de que estos metabolitos existiesen en las muestras de carne, éstos deberían proceder de la degradación de los compuestos originales. Como su estructura química sería diferente a la del compuesto original, pasarían inadvertidos para las técnicas cromatográficas empleadas en control oficial, dirigidas a la detección de compuestos marcador definidos por la legislación (Reg. 37/2010 para sustancias autorizadas y 2019/1871 para las no autorizadas).
FIGURA 1
Para comprobar esta hipótesis, se estudiaron muestras de carne congeladas procedentes del banco de muestras construido por Serrano et al. (2020), con concentraciones conocidas de antibióticos (deteminadas por QTOF en 2018), envasadas al vacío y mantenidas en congelación a -20°C desde entonces hasta su re-análisis mediante el test de cribado y análisis cromatográfico QTOF en 2021.
Los análisis cromatográficos detectaron degradación de los antibióticos (P ≤ 0.05) diferente en función del compuesto (Figura 1)
La oxitetraciclina no mostró degradación.
La amoxicilina se degradó de forma completa.
La enrofloxacina (26-55% de degradación) y la sulfametoxipiridazina (5-39%) mostraron un comportamiento intermedio.
La degradación de antibióticos tras el almacenamiento en congelación ya ha sido descrita previamente (Shaltout et al., 2019).
Concentraciones de antimicrobianos detectadas en 2018 ( ) y 2021 ( ) en muestras de carne del banco de muestras contaminadas de forma natural con amoxicilina (A1, A2, A3, A4), sulfametoxipiridazina (S1, S2, S3), oxitetraciclina (O1, O2, O3, O4) y enrofloxacina (E1, E2, E3).
De acuerdo a los análisis cromatográficos, algunas de las muestras de amoxicilina y sulfametoxipiridazina (A1, A3, A4 y S3; Figura 1), experimentaron una degradación a niveles inferiores a los detectables por la técnica cromatográfica, pero seguían siendo positivas al cribado, lo que apuntaba a la presencia de actividad antibacteriana derivada de los compuestos de degradación de los antibióticos originales, que pasarían desapercibidos para la técnica cromatográfica empleada.
2500 2000 1500 1000 500 0 A1 A2 A3 A4 S1 S2 S3 O1 O2 O3 O4 E1 E2 E3 2018 2021
ONE HEALTH 71
Para confirmarlo, se llevaron a cabo los experimentos que se detallan a continuación. Presencia de metabolitos de ß-lactámicos biológicamente activos en muestras de carne naturalmente contaminadas con amoxicilina (detección basada en reconocimiento bioquímico estructural)
BTScan® (Zeulab, Zaragoza, España) es un test actualmente comercializado, basado en inmunocromatografía de flujo lateral que detecta la presencia de ß-lactámicos y tetraciclinas.
Para evaluar la presencia potencial de metabolitos activos de ß-lactámicos en muestras de carne, se tomaron 4 muestras de carne procedentes del banco de muestras (Serrano et al., 2020), caracterizadas por cromatografía LC-MS/MS en 2018, y se re-analizaron en 2021.
La Tabla 8 muestra que, a pesar de que el antibiótico se degradaba por completo tras 3 años de almacenamiento, las muestras seguían siendo capaces de inhibir el crecimiento del microorganismo diana del test de cribado, no solo en 2018, cuando se detectaban elevadas concentraciones, sino también en 2021.
El análisis en paralelo con BTScan® demostró la presencia de metabolitos de ß-lactámicos en todas las muestras analizadas.
Así, existen metabolitos biológicamente activos de amoxicilina en muestras de músculo procedentes de su degradación durante el almacenamiento en congelación que podrían ser responsables de resultados positivos en tests de cribado de base biológica, pudiendo pasar desapercibidos para técnicas cromatográficas empleadas rutinariamente en control oficial.
Detección de metabolitos de sulfamidas basada en inhibición competitiva de su actividad biológica
Las sulfamidas son compuestos antimicrobianos con actividad bacteriostática relacionada con la inhibición de la síntesis del ADN, compitiendo con el ácido paraminobenzóico (pABA), necesario para la síntesis de ácido fólico en bacterias.
Para comprobar la presencia de sulfamidas, se tomaron 8 muestras de carne procedentes del banco de muestras (Serrano et al., 2020), contaminadas con sulfamidas a concentraciones inferiores al LMR, y se analizaron mediante el cribado de amplio espectro de antibióticos antes y después de la adición de 50 μg/mL de pABA (FIL/IDF, 1991; Sanz et al., 2015).
La Figura 2A ilustra la positividad de las muestras antes de la adición de pABA (valores del cribado acoplado a e-Reader® por encima del cut-off o valor del método por encima del cual una muestra se considera positiva) y cómo el efecto inhibitorio desapareció tras la adición de pABA (P ≤ 0.05), lo que demuestra la competencia de este compuesto con metabolitos biológicamente activos presentes en la carne, presumiblemente procedentes de la degradación de la sulfamida original con la que se trató a los animales y que no se detectaron por la técnica cromatográfica dirigida.
Además, se re-analizaron 18 muestras de carne comercial recogidas en el presente estudio, positivas al cribado, pero negativas a los análisis cromatográficos por QTOF, de las cuales solo 3 seguían manteniendo positividad tras 8 meses en congelación (S12-S14, Figura 2B).
Tras la adición de pABA, se constató que se revertía el efecto inhibitorio (P ≤ 0.05) en 2 de ellas (S13 y S14), hecho que apunta a la presencia de metabolitos biológicamente activos de sulfamidas.
La fiabilidad del pABA se comprobó con la muestra S15, una muestra de carne comercial que, caracterizada por QTOF, contenía 82 μg/kg de sulfadiazina en el momento de su recogida, y positiva al cribado incluso tras 8 meses de almacenamiento en congelación, ya que, tal y como muestra la la Figura 2 , hubo pérdida de la capacidad inhibitoria de la sulfamida tras la adición de pABA.
ANTIMICROBIANOS Nº 8 | Julio 2023 Antibióticos y carne: un enfoque novedoso en los métodos de vigilancia 72
Estos hallazgos demostraron la presencia en carne de metabolitos biológicamente activos procedentes de los antibióticos originales.

Así pues, los análisis cromatográficos ofrecen la ventaja de la caracterización de las muestras (identificación + cuantificación del antibiótico), pero su análisis no detecta la presencia de estos metabolitos debido a su carácter dirigido. Es por esto que los test biológicos de cribado ofrecen ciertos beneficios, puesto que permiten detectar de manera directa la actividad biológica de los antibióticos y sus metabolitos.
TABLA 8
Análisis cromatográficos (HPLC-MS/MS) y resultados del cribado de amplio espectro de antibióticos de 4 muestras de carne contaminadas con amoxicilina, obtenidos tras el análisis de estas muestras en 2018 y 2021, momento en el cual también se analizaron por inmunocromatografía de flujo lateral. Los valores numéricos están expresados en µk/kg, los resultados positivos con el símbolo +, y los resultados próximos al positivo, con el símbolo ±.
*Puesto que la técnica está optimizada para el análisis de ß-lactámicos en leche, para evitar el efecto matriz, se llevó a cabo una dilución 20/80 v/v de suero de carne en leche. Las muestras con resultados ± se corresponden con muestras cuyos resultados encajan con la presencia de ß-lactámicos, teniendo en cuenta el factor dilución 1/5.
HPLC-MS/MS Explorer® BTScan® 1/5* 2018 2021 2018 2021 2021 A1 2.254 < LoD + + + A2 429 29 + + + A3 532 < LoD + + ± A4 72 < LoD + + ±
ONE HEALTH 73
FIGURA 2
A. Resultados del cribado de amplio espectro de antibióticos acoplado a e-Reader® tras el análisis de 8 muestras de carne de animales tratados con sulfametoxipiridazina procedentes del banco de muestras antes ( ) y después ( ) de la adición de pABA. La línea discontinua roja representa el cut-off del test Explorer® por encima del cual los resultados se consideran positivos.
B. Resultados del cribado de amplio espectro de antibióticos acoplado a e-Reader® tras el análisis de 4 muestras de carne comercial recogidas en este estudio antes ( ) y después ( ) de la adición de pABA. La línea discontinua roja representa el cut-off del test de cribado por encima del cual los resultados se consideran positivos.
CONCLUSIONES
El análisis secuencial (cribado + confirmación) de 5.357 muestras de carne comercializada del área transfronteriza España-Francia mostró un 3,6% de muestras positivas al cribado mientras que los análisis cromatográficos dirigidos (QTOF) mostraron no conformidad en el 0,093%, datos similares a los publicados por la EFSA para 2019.
LAS FAMILIAS MÁS DETECTADAS FUERON
TETRACICLINAS, SULFAMIDAS, QUINOLONAS, LINCOMICINA Y ß-LACTÁMICOS
Pruebas adicionales demostraron la presencia de metabolitos biológicamente activos procedentes de la degradación del antibiótico original detectados por el test biológico de cribado de amplio espectro de antibióticos, pero no por la cromatografía dirigida empleada en este estudio y en los controles oficiales.
Por ello, en caso de que primen los requerimientos legales, los análisis cromatográficos dirigidos a la detección de los compuestos marcador (Reglamento 37/2010) serán de elección. Sin embargo, si se busca ofrecer protección extra a los consumidores, deberían usarse tests de cribado de tipo biológico.
100 80 60 40 20 0 S4 S5 S6 S7 S8 S9 S10 S11 A Resultados de e-Reader ® 120 100 80 60 40 20 0 S12 S13 S14 S15 B V alor de e-Reader ® ANTIMICROBIANOS Nº 8 | Julio 2023 Antibióticos y carne: un enfoque novedoso en los métodos de vigilancia 74
Agradecimientos
El proyecto ha sido cofinanciado al 65% por el Fondo Europeo de Desarrollo Regional (FEDER) a través del Interreg V-A España, Francia, Andorra (POCTEFA 2014-2020). El objetivo de POCTEFA es reforzar la integración económica y social de la zona fronteriza España-FranciaAndorra. Su ayuda se concentra en el desarrollo de actividades económicas, sociales y medioambientales transfronterizas a través de estrategias conjuntas a favor del desarrollo territorial sostenible.
BIBLIOGRAFÍA
1. Agreste, 2020. Ministere de l´Agriculture et de l´Alimentation. Agreste, la statistique, l´évaluation et la prospective agricole. Synthesis conjuncturelles. La consummation de viande en France en 2019. June 2020. Recuperado de: https://www.franceagrimer. fr/fam/content/download/64687/ document/NCO-VIA-Consommation%20 de%20viandes%20en%20France-2019.
pdf?version=1. Consultado: 14 de julio de 2020.
2. Brown, K., Uwiera, R. R., Kalmokoff, M. L., Brooks, S. P. & Inglis, G. D. (2007). Antimicrobial growth promoter use in livestock: a requirement to understand their modes of action to develop effective alternatives. International Journal of Antimicrobial Agents, 49(1), 12-24.
3. De Haro, 2015. Efecto de los Aceites Esenciales de Plantas Aromático-Medicinales en la Fase de Transición de Animales Monogástricos. Tesis doctoral. Universidad de Murcia. Recuperado de: https://digitum.um.es/digitum/ bitstream/10201/43769/1/Tesis_MDHG.
pdf.Consultado: 22 de mayo de 2021.
4. Diana, A., Santinello, M., Penasa, M., Scali, F., Magni, E., Alborali, G. L., Bertocchi, L.; De Marchi, M. (2020). Use of antimicrobials in beef cattle: an observational study in the north of Italy. Preventive Veterinary Medicine, 81, 105032.
5. EFSA, 2017. ECDC (European Centre for Disease Prevention and Control), EFSA (European Food Safety Authority) and EMA (European Medicines Agency). ECDC/ EFSA/EMA Second Joint Report on the Integrated Analysis of the Consumption of Antimicrobial Agents and Occurrence of Antimicrobial Resistance in Bacteria from Humans and Food-Producing Animals. Joint Interagency Antimicrobial Consumption and Resistance. Analysis (JIACRA) Report. EFSA Journal, 15, e04872. Recuperado de: https://www.ecdc.europa.eu/sites/ default/files/documents/efs2_4872_final. pdf. Consultado: 10 de noviembre de 2020.

6. EFSA, 2021a. European Centre for Disease Prevention and Control (ECDC), European Food Safety Authority (EFSA), & European Medicines Agency (EMA). (2021). Third joint inter‐agency report on integrated analysis of consumption of antimicrobial agents and occurrence of antimicrobial resistance in bacteria from humans and food‐producing animals in the EU/EEA: JIACRA III 2016‐2018. EFSA Journal, 19(6), e06712.
7. EFSA, 2021b. Report for 2019 on the
results from the monitoring of veterinary medicinal product residues and other substances in live animals and animal products. (2021) Recuperado de: https:// efsa.onlinelibrary.wiley.com/doi/ epdf/10.2903/sp.efsa.2021.EN-1997 Consultado:12 de septiembre de 2021.
8. EMA, 2020. Categorisation of antibiotics for use in animals for prudent and responsible use. Recuperado de: https:// www.ema.europa.eu/en/documents/ report/infographic-categorisation-antibiotics-useanimals-prudent-responsible-use_ en.pdf Consultado el 27 de abril de 2021.
9. EMA, 2021. Sales of veterinary antimicrobial agents in 31 European countries in 2019 and 2020. Recuperado de: https://www.ema.europa.eu/en/ documents/report/sales-veterinary-antimicrobial-agents-31-european-countri es-2019-2020-trends-2010-2020-eleventh_en.pdf Consultado: 14 de julio de 2021.
10. Eurostat, 2020. Estatistics Explained. Agricultural production - livestock and meat. Recuperado de: https://ec.europa.eu/ eurostat/statistics-explained/index.php?title=Agricultural_production_-_livestock_ and_meat&oldid=427096#Meat_production. Consultado: 28 de octubre de 2021,
11. FAO, 2021. Food and Agriculture Organization of the United Nations. Food Supply - Livestock and Fish Primary Equivalent. Recuperado de: https://www.fao.org/faostat/en/#data/
CL. Consultado: 29: de junio de 2021.
12. FIL/IDF International Dairy Federation. (1991). Detection and confirmation of inhibitors in milk and milk products. IDF Bulletin 258. Bruselas, Bélgica. pp 99.
13. Hamscher, G., Pawelzick, H. T., Höper, H. & Nau, H. (2005). Different behavior of tetracyclines and sulfonamides in sandy soils after repeated fertilization with liquid manure. Environmental Toxicology and Chemistry, 24(4), 861-868.
14. Kanerva, M. (2013). Meat consumption in Europe: Issues, trends and debates. Recuperado de: https://www.ssoar.info/ ssoar/bitstream/handle/document/58710/ ssoar-2013-kanerva-Meat_consumption_ in_Europe_issues.pdf?sequence=3.
Consultado: 15 de septiembre de 2020.
15. MAPA, 2019. Ministerio de Agricultura, Pesca y Alimentación. Informe del consume de alimentación en España 2019. Recuperado de: https://www.mapa.gob. es/en/alimentacion/temas/consumo-tendencias/informe2019_v2_tcm38-540250. pdf. Consultado: 10 de octubre de 2021.
16. Mata, L.; Sanz, D.; Razquin, P. Validation of the Explorer® 2.0 test coupled to e-Reader® for the screening of antimicrobials in muscle from different animal species. Food Addit. Contam.: Part A 2014, 31, 1496-1505.
17. Omonijo, F. A., Ni, L., Gong, J., Wang, Q., Lahaye, L., & Yang, C. (2018). Essential oils as alternatives to antibiotics in swine production. Animal Nutrition, 4(2), 126-136.
18. OMS, 2021. World Health Organization. Antimicrobial resistance. Recuperado de: https://www.who.int/news-room/ fact-sheets/detail/antimicrobial-resistance Consultado: 20 de noviembre de 2021.
19. Sanz, D.; Razquin, P.; Condón, S.; Juan, T.; Herráiz, B.; Mata, L. Incidence of antimicrobial residues in meat using a broad spectrum screening strategy. European Journal of. Nutrition and Food Safety. 2015, 5, 156-165.
20. Sarmah, A. K., Meyer, M. T., & Boxall, A. B. (2006). A global perspective on the use, sales, exposure pathways, occurrence, fate and effects of veterinary antibiotics (VAs) in the environment. Chemosphere, 65(5), 725-759.
21. Serrano, M. J., Elorduy, J., Zabaleta, I., Istamboulie, G., González-Fandos, E., Bousquet-Mélou, A., ... & Pagán, R. (2022). Antimicrobial residue assessment in 5,357 commercialized meat samples from the Spain-France cross-border area: A new approach for effective monitoring. Food Control, 138, 109033.
22. Serrano, M. J., Mitjana, O., Bonastre, C., Laborda, A., Falceto, M. V., García-Gonzalo, D., ... & Pagán, R. (2020). Is blood a good indicator for detecting antimicrobials in meat? Evidence for the development of in vivo surveillance methods. Antibiotics, 9(4), 175.
23. Shaltout, F. A. E., Shatter, M. A. E., & Sayed, N. F. (2019). Impacts of different types of cooking and freezing on antibiotic residues in chicken meat. Journal of Food Science and Nutrition, 5, 045.
24. Voundi, S. O., Nyegue, M., Lazar, I., Raducanu, D., Ndoye, F. F., Stamate, M., & Etoa, F. X. (2015). Effect of essential oils on germination and growth of some pathogenic and spoilage sporeforming bacteria. Foodborne pathogens and disease, 12(6), 551-559.
25. Wang, S., Zeng, X., Yang, Q., & Qiao, S. (2016). Antimicrobial peptides as potential alternatives to antibiotics in food animal industry. International journal of molecular sciences, 17(5), 603.
26. Zhou, X., Wang, J., Lu, C., Liao, Q., Gudda, F. O., & Ling, W. (2020). Antibiotics in animal manure and manure-based fertilizers: Occurrence and ecological risk assessment. Chemosphere, 255, 127006.
ONE HEALTH 75
IMPACTO DEL CONTROL DE LA
COCCIDIOSIS Y LA ANEMIA FERROPÉNICA EN LA CALIDAD DEL LECHÓN AL DESTETE
En el momento del nacimiento los lechones presentan unas reservas de hierro escasas. Este hecho, unido a la baja concentración de hierro de la leche de la cerda y a la alta actividad eritropoyética del lechón durante sus primeras semanas de vida, hace imprescindible la administración de hierro exógeno al lechón en las condiciones actuales de cría intensiva. La administración de hierro permite cubrir las necesidades del lechón para la síntesis de hemoglobina, mioglobina y otras enzimas. En cambio, si las necesidades de hierro no son cubiertas se desarrolla la ANEMIA FERROPÉNICA DEL LECHÓN.
1Departamento de Patología Animal, Universidad de Zaragoza
2Grupo Mazana
3CEVA Salud Animal
Esta no es la única condición adversa a la que los lechones han de enfrentarse durante la fase de lactación, ya que, a los pocos días tras su nacimiento, con elevada probabilidad, serán colonizados por Cystoisospora suis (C. suis), un protozoo intracelular endémico en las granjas porcinas. Es más, si se dan las condiciones adecuadas para el desarrollo de su ciclo vital, este protozoo desencadenará una destrucción de los enterocitos dando lugar a la COCCIDIOSIS PORCINA.
*Adaptación del artículo: Impact of controlling coccidiosis and iron deficiency anaemia on piglet quality at weaning. Proceedings of 13th European Symposium of Porcine Health and Management, 11-13 May 2022, Budapest

C
E.
E. Udvarhelyi1, L. Villagrasa2 , T. Abizanda2 , O. Mitjana1, M.V. Falceto1, D. Espigares 3 , L. Garza-Moreno1,3
Nº 8 | Julio 2023 SANIDAD Impacto del control de la coccidiosis y la anemia ferropénica en la calidad del lechón al destete 76
Descarga el PDF
ABORDAJE TRADICIONAL DE LA ANEMIA FERROPÉNICA Y COCCIDIOSIS PORCINA
PREVENCIÓN DE LA ANEMIA FERROPÉNICA
Tradicionalmente, la prevención de la anemia ferropénica de los lechones se ha basado en la administración intramuscular de compuestos derivados del hierro como gleptoferrón o hierro dextrano.
PREVENCIÓN DE LA COCCIDIOSIS PORCINA
De forma similar, la prevención de la coccidiosis porcina se ha realizado mediante la administración vía oral de toltrazurilo.

Ambas aplicaciones de productos forman parte de lo que comúnmente se denomina el procesado de las camadas que consiste en la realización de una serie de actuaciones sobre el lechón durante el segundo o tercer día de vida encaminados a incrementar su tasa de supervivencia a lo largo de su vida productiva.
LA AFECTACIÓN DE LOS LECHONES POR ANEMIA FERROPÉNICA, POR COCCIDIOSIS O POR AMBOS
PROCESOS CONLLEVA UNA REDUCCIÓN EN LOS PARÁMETROS DE CRECIMIENTO DURANTE LA FASE DE LACTACIÓN
Esta afectación tiene como consecuencia una reducción del peso al destete, con los consiguientes efectos perniciosos en el rendimiento productivo de los animales durante las fases inmediatamente posteriores de su vida.
C
LECHONES 77
DOS PROBLEMAS, UNA SOLUCIÓN
MATERIAL Y MÉTODOS RESULTADOS
El objetivo de esta prueba fue comparar un producto combinado a base de gleptoferrón y toltrazurilo en forma inyectable (Forceris®) con la administración tradicional de toltrazurilo oral y gleptoferrón inyectable.
Para ello, se seleccionó una granja de 3.300 reproductoras con producción de lechón a destete (fase 1) en bandas semanales. La prueba comparativa se realizó durante 3 lotes consecutivos en los que las camadas fueron asignadas aleatoriamente a dos grupos de tratamiento (Grupo B y Grupo F).
Un total de 46 camadas con 662 lechones fueron incluidos en el estudio, correspondiendo 338 lechones y 23 camadas al Grupo F y 324 lechones y 23 camadas al Grupo B.
En el procesado de las camadas al 2º-3º día de vida, los lechones de las distintas camadas fueron identificados individualmente, limitándose el movimiento de lechones entre camadas durante el desarrollo de la prueba.
GRUPO B (23 CAMADAS Y 324 LECHONES)
Los lechones de las camadas incluidas en el grupo B recibieron toltrazurilo por vía oral junto con gleptoferrón vía intramuscular.
GRUPO F (23 CAMADAS Y 338 LECHONES)
A los lechones del grupo F se les administró 1,5 ml de Toltrazurilo y Gleptoferrón (Forceris®) vía intramuscular.
Los lechones fueron pesados individualmente con báscula electrónica de precisión en el momento de aplicación de los productos y en el momento previo al destete, calculándose así la ganancia media diaria (GMD) de cada lechón durante la fase de lactación como la variable principal de eficacia a valorar a la finalización de la prueba.

No se detectaron diferencias estadísticamente significativas entre ambos grupos en el peso al inicio de la prueba (peso al procesado), quedando los animales de ambos grupos equilibrados en cuanto a peso inicial.
En las Tablas 1-4 se muestran los resultados para cada uno de los lotes, así como los resultados totales.
Globalmente, teniendo en cuenta todos los animales incluidos en el estudio (Tabla 1), se observó una diferencia en la ganancia total de peso de 341 g a favor del Grupo F, lo que supuso 19 g más de GMD para los lechones pertenecientes a este grupo de tratamiento, siendo estas diferencias estadísticamente significativas (p<0,05).
Tratamiento (Grupo) Lechones totales (n) Días de lactación Media de pesos al procesado (kg) Media pesos al destete (kg) DIF (Diferencia entre pesos: procesado/ destete) GMD (kg) Forceris® (Grupo F) 338 20,4 1,799 ± 0,601 6,249 ± 1,735 4,450 ± 1,628 0,217 ± 0,078 Tratamiento habitual (Grupo B) 324 20,7 1,807 ± 0,535 5,907 ± 1,663 4,099 ± 1,416 0,197 ± 0,071 + 351 g + 19 g/día TABLA 1
Resultados globales del estudio comparativo de la ganancia de peso de los lechones de los Grupos F y B.
Nº 8 | Julio 2023 SANIDAD Impacto del control de la coccidiosis y la anemia ferropénica en la calidad del lechón al destete 78
TABLA 2
Resultados del lote 1 del estudio comparativo de la ganancia de peso de los lechones de los Grupos F y B.
TABLA 3
Resultados del lote 2 del estudio comparativo de la ganancia de peso de los lechones de los Grupos F y B.
Las diferencias detectadas fueron diferentes en los 3 lotes evaluados, observándose que estas diferencias se iban incrementando lote tras lote, siendo más acentuadas en el
lote que en el
DISCUSIÓN
TABLA 4
Resultados del lote 3 del estudio comparativo de la ganancia de peso de los lechones de los Grupos F y B.
Teniendo en cuenta que ambos grupos fueron tratados con gleptoferrón, el mayor crecimiento detectado en los animales pertenecientes al Grupo F podría estar asociado a un mejor control de la infección por C. suis, dado que la presencia de este patógeno de forma endémica en la granja estaba confirmada con anterioridad.
La eficacia del toltrazurilo administrado por vía oral o por vía inyectable ha sido confirmada en previas publicaciones. No obstante, diversos estudios realizados tras el desarrollo del toltrazurilo en aplicación inyectable, confirman que la presencia de metabolitos efectivos del toltrazurilo a nivel sistémico

en los animales es más elevada. Tratamiento (Grupo) Lechones totales (n) Días de lactación Media de pesos al procesado (kg) Media pesos al destete (kg) DIF (Diferencia entre pesos: procesado/ destete) GMD (kg) Forceris® (Grupo F) 124 19,3 1,969 ± 0,748 6,358 ± 1,328 4,389 ± 1,393 0,228 ± 0,073 Tratamiento habitual (Grupo B) 97 19,8 1,963 ± 0,546 6,427 ± 1,611 4,464 ± 1,422 0,221 ± 0,074 + 75 g + 7 g/día Tratamiento (Grupo) Lechones totales (n) Días de lactación Media de pesos al procesado (kg) Media pesos al destete (kg) DIF (Diferencia entre pesos: procesado/ destete) GMD (kg) Forceris® (Grupo F) 111 20,0 1,863 ± 0,400 6,168 ± 1,597 4,342 ± 1,384 0,217 ± 0,069 Tratamiento habitual (Grupo B) 111 20,2 2,060 ± 0,511 6,172 ± 1,544 4,112 ± 1,248 0,205 ± 0,062 + 230 g + 12 g/día Tratamiento (Grupo) Lechones totales (n) Días de lactación Media de pesos al procesado (kg) Media pesos al destete (kg) DIF (Diferencia entre pesos: procesado/ destete) GMD (kg) Forceris® (Grupo F) 103 22,3 1,580 ± 0,510 6,392 ± 2,224 4,813 ± 2,021 0,217 ± 0,092 Tratamiento habitual (Grupo B) 116 22,0 1,439 ± 0,294 5,234 ± 1,627 3,895 ± 1,518 0,177 ± 0,069 + 917 g + 40 g/día
primero. GANANCIA DE PESO Y CONTROL DE C. SUIS GANANCIA DE PESO Y CONTROL DE C. SUIS
tercer
LECHONES 79
ESTE HALLAZGO PODRÍA IMPLICAR UN INCREMENTO EN LA EFICACIA
COCCIDICIDA DEL PRODUCTO A NIVEL INTRACELULAR Y, EN CONSECUENCIA,
UNA MAYOR EFICACIA DE LA FORMA INYECTABLE SOBRE LA FORMA ORAL
CARGA AMBIENTAL DE C. SUIS
CARGA AMBIENTAL DE C. SUIS
Una de las principales ventajas que refleja la forma inyectable es la mayor facilidad de aplicación de la dosis correcta por esta vía.
Frecuentemente, la aplicación oral conlleva una subdosificación del producto derivada de una administración deficiente por parte del operario o de la capacidad de los lechones de escupir y/o vomitar el producto una vez aplicado.
Otro hecho reseñable en los resultados del presente estudio fue el incremento de las diferencias observadas en los consecutivos lotes en cuanto a la carga ambiental de C. suis, que podrían ser cada vez mayores hasta llegar a un nivel de carga ambiental mínima.
EL TRATAMIENTO Y CONTROL MÁS EFICIENTE DE C. SUIS PODRÍA REDUCIR LA CARGA AMBIENTAL DEL MISMO
En este escenario, la afectación por el parásito sería mínima y, en consecuencia, su impacto sobre el crecimiento también. De este modo, se alcanzaría una situación estable en la que ya no se observarían diferencias entre lotes consecutivos. No obstante, sería necesario realizar más estudios al respecto para profundizar y poder confirmar estos resultados.
EFICIENCIA Y RETORNO DE LA INVERSIÓN
EFICIENCIA Y RETORNO DE LA INVERSIÓN
Únicamente teniendo en cuenta un incremento de peso al destete de 341 g, en el contexto actual de precios, supone para la empresa productora un rendimiento adicional de 0,70 €/lechón. A este beneficio se añade un procesado del lechón más eficiente en tiempo.
Esta eficiencia se constató en otros estudios en los que se midió el tiempo invertido en realizar la aplicación oral de toltrazurilo e inyectable de hierro versus una única aplicación inyectable de ambos productos dentro del procesado de los lechones.
CONCLUSIONES
En las condiciones del presente estudio, la eficacia de Forceris® en el control de la coccidiosis porcina y la anemia ferropénica quedó confirmada en términos de una mayor GMD de los animales durante la fase de lactación.
Estas mejoras en el crecimiento de los animales redundan en una mejora del rendimiento económico de los animales al destete, así como un procesado más eficiente de los lechones con un menor manejo y, por consiguiente, un mayor bienestar para los lechones recién nacidos.

Nº 8 | Julio 2023 SANIDAD Impacto del control de la coccidiosis y la anemia ferropénica en la calidad del lechón al destete 80
Siempre fuerte | Siempre a tu lado
FUERZA INNOVADORA
Una sola inyección para una doble protección
Tratamiento inyectable

único

Prevención de la anemia ferropénica y la coccidiosis
Disminuye la excreción de ooquistes y previene la diarrea
Facilita el trabajo de veterinarios, técnicos y productores: comodidad y ahorro de tiempo
Ficha técnica
Consulta con tu Veterinaro

SUSCRÍBASE
El medio técnico-científico, innovador y exclusivo para veterinarios de porcino porcinews.com/revista-porcisapiens porciSapiens® agriNews®
GRATIS
























 EXPRESIÓN GÉNICA
EXPRESIÓN GÉNICA
EXPRESIÓN GÉNICA
EXPRESIÓN GÉNICA





























 Manuel Martínez Ruiz Veterinario de ASOPORCEL
Manuel Martínez Ruiz Veterinario de ASOPORCEL









 Titular de Medicina y Reproducción Porcina
Titular de Medicina y Reproducción Porcina















































 FIGURA 1
FIGURA 2
FIGURA 1
FIGURA 2